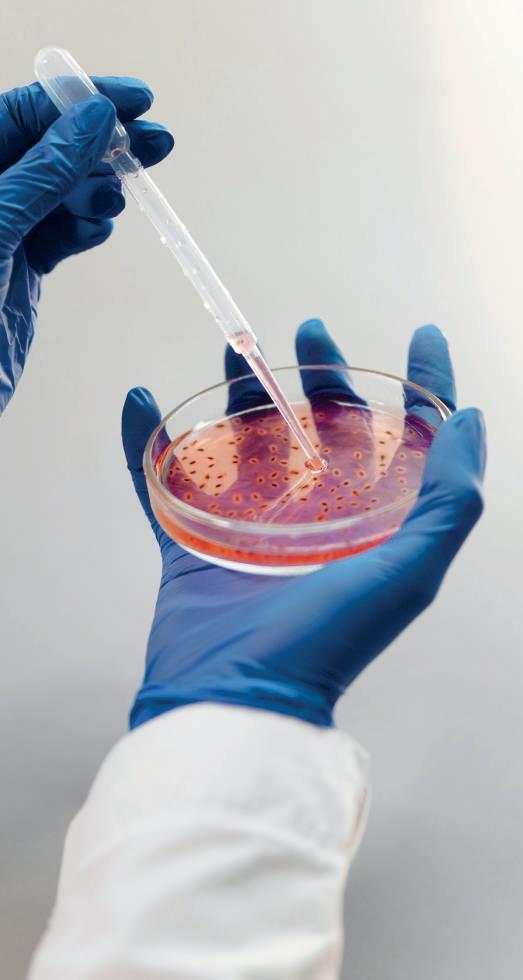

Peer Reviewed
Beyond Symptom Relief: Human iPSC-derived Models for the Development of Life-changing Therapies for Neurodegenerative Diseases
The Opportunities and Obstacles of Filling and Packaging Pre-filled Syringes
The Future of the Connected Drug Delivery Device Market: Key Areas for Innovation

Notes on Causal Inference For the Layman
Sponsor Company:


Volume 6 Issue 1
www.international-biopharma.com
Discover the solution to your sterile fill & finish needs
Recipharm has a wealth of experience providing contract sterile filling to customers around the world.
Talk to our experts and experience the problem-solving power of our people.
Meet us at the BIO International Convention in Boston, June 5–8 at Booth #485, and discover the genius of working together.
Supporting your small and large molecule sterile fill & finish needs

Liquid vials
Lyophilised vials
Pre-filled syringes
Cartridges
Blow-fill-seal Ampoules
Spring 2023 Volume 6 Issue 1
Book a meeting
DIRECTOR: Mark A. Barker
INTERNATIONAL MEDIA DIRECTOR: Anthony Stewart anthony@senglobalcoms.com
EDITORIAL MANAGER: Beatriz Romao beatriz@senglobalcoms.com
DESIGN DIRECTOR: Jana Sukenikova www.fanahshapeless.com
FINANCE DEPARTMENT: Akash Sharma accounts@senglobal.co.uk
RESEARCH & CIRCULATION: Jessica Chapman jessica@senglobalcoms.com
COVER IMAGE: iStockphoto ©
PUBLISHED BY: Senglobal ltd.
Unit 5.02, E1 Studios, 7 Whitechapel Road, E1 1DU, United Kingdom
Tel: +44 (0)20 4541 7569 Email: info@senglobalcoms.com www.international-biopharma.com
All rights reserved. No part of this publication may be reproduced, duplicated, stored in any retrieval system or transmitted in any form by any means without prior written permission of the Publishers.
The next issue of IBI will be published in Summer 2023.
ISSN No.International Biopharmaceutical Industry ISSN 1755-4578.
The opinions and views expressed by the authors in this journal are not necessarily those of the Editor or the Publisher. Please note that although care is taken in the preparation of this publication, the Editor and the Publisher are not responsible for opinions, views, and inaccuracies in the articles. Great care is taken concerning artwork supplied, but the Publisher cannot be held responsible for any loss or damage incurred. This publication is protected by copyright.
2023 Senglobal ltd.
Volume 6 Issue 1 – Spring 2023
04 Foreword
TALKING POINT
06 Global Sterile Manufacturing and Lyophilization Capabilities of Large and Small Molecule Biologics –PCI Shows the Way
IBI speaks with Shawn Cain of PCI, in relation to global manufacturing capabilities of complex formulations, high potency, and lyophilization and their capabilities covering a broad range of injectables including nanoparticles, mRNA, mAbs, proteins, oligonucleotides, and other biologics across multiple delivery formats.
10 High Accuracy Flow Meter for Low Flow Measurements
With the growing popularity of micro-bioreactors, perfusion, as well as cell & gene therapy applications in the life sciences industry, the need to measure low flow rates non-invasively is ever increasing. In this application note, Nico Polley at SONOTEC GmbH explains how the new SONOFLOW CO.55 V3.0 non-contact clamp-on flow meter pushes the boundaries of low flow measurement in flexible tubing.
REGULATORY & COMPLIANCE
12 Generating Powerful New Pharma Insights from Graphs

An interesting possibility is emerging for the life sciences industry. Can we use a new approach to organising complex data to gain a more holistic view of the underlying problems we want to address?
The new approach is knowledge graph, which is defined by the AI research group The Alan Turing Institute as capturing information about entities of interest in a given domain or task and finding the connections between them. Alex Jarasch of Neo4j, explains how knowledge graphs can be a valuable asset for the pharmaceutical industry to extract insights from complex data.
16 Causal Inference and the Future of Clinical Trials
Clinical trials are typically designed so that the effectiveness of a treatment on a specific outcome can be assessed. There exist many other factors that can influence the outcome, as well as the inputs themselves and they may be known, observed or not or even unknown to the experimenter, and it is often impractical or impossible to keep all of them under direct control. Ivano Lodato of Allos AI, discusses how the causal inference analysis explained constitutes the mathematical formalism through which complex and delicate questions can be approached, and in some cases answered without bias and in a purely explainable way, thanks to the causal graph structure.
INTERNATIONAL BIOPHARMACEUTICAL INDUSTRY 1 www.international-biopharma.com
Contents
RESEARCH / INNOVATION / DEVELOPMENT
20 The Future of the Connected Drug Delivery Device Market: Key Areas for Innovation

The past two decades have seen huge growth in the market for injectable drug delivery products; this shows little sign of slowing. Biotherapeutics have played a significant part, with biologics and biosimilars mostly administered via subcutaneous injection. With a growing number of biosimilars set to come onto the market, we are likely to see the market for subcutaneous drug delivery devices develop further. Michael Earl at Owen Mumford explains that with rapid growth and investment in the connected drug delivery device industry, benefits arising from connected devices are exploited to the fullest.
MANUFACTURING & PROCESSING
24 The Opportunities and Obstacles of Filling and Packaging Pre-filled Syringes
Pre-filled syringes offer plenty of advantages for injectable drug formulations, but also have challenges ranging from sterile integrity requirements to packaging. Robert Fielders at Recipharm, presents the benefits that the PFS format gives the pharmaceutical industry and patients and provides advice to solve the common challenges associated with PFS filling and packaging.
28 Are Nitrosamines a Concern for Biologic Manufacturers?
First described over a century ago, the class of organics known as N-nitrosamines are defined by the common structural feature, R2NNO. Since the mid-1950s when their carcinogenic nature was revealed. Clearly, there can be no single approach to solving the nitrosamine challenge and, even for the same product, a variety of solutions may be considered appropriate. In 2020 the EMA published an assessment report10 that directed all medicinal products, including biologics, into the scope of nitrosamine risk assessment. Mark Rogers of SGS discusses how the significant diversity in molecular type, manufacturing processes and supply chains used for biologic therapeutics create new potential routes for nitrosation, and why it is therefore critical that the industry maintains its vigilance vis-à-vis these harmful impurities.
32 Analytical Method Release and Stability Platform for RNA Drug Substance
As a leader in cell and gene therapy (CGT) manufacturing and testing for 25 years, Aldevron has built superior analytical capabilities and expertise to support characterisation, release, and stability testing of internally manufactured products. In this Application Note, experts at Aldevron explains, that with strong commitment to assay life cycle management, they are dedicated to continuously improving methods and adding innovative technologies.
THERAPEUTICS
36 Beyond Symptom Relief: Human iPSC-derived Models for the Development of Life-changing Therapies for Neurodegenerative Diseases
The complexity and epidemiology of neurodegenerative diseases demands the incorporation of alternative approaches for the development of disease-modifying therapies that can bring real improvements to patients. iPSC-derived models are based on human biology offering unique characteristics which are greatly benefiting early and preclinical drug development. Noelia
Muñoz-Martín and Shushant Jain at Ncardia discuss the status of drug discovery and development for Alzheimer’s disease (AD), Parkinson’s disease (PD) and Amyotrophic Lateral Sclerosis (ALS), focusing on promising candidates identified with the help of iPSC technology.
44 The One that Gut Away –Measuring Microbial VOCs from Breath
Non-invasive tools that are effective for disease screening, diagnosis and monitoring remain an unmet need in many disease areas. Tina Chou at Owlstone Medical discusses breath volatile organic compounds (VOCs) can serve as non-invasive biomarkers, and how breath, in addition to faecal VOCs, has the potential to reflect gut microbial activities, making it highly favourable for clinical application.
TECHNOLOGY
48 Multiparticulates: A Flexible Approach for New Dosage Forms
Multiparticulate (MP) technology is a well-established and versatile tool for solving a wide range of drug delivery problem statements, including oral modified and controlled release, developing patient-centric dosage forms, and achieving flexibility in dose and dosage form presentation. Jonathan Cape of Bend Research and et al explains how multiparticulates can contribuite to a flexible approach for new dosage forms.
2 INTERNATIONAL BIOPHARMACEUTICAL INDUSTRY Spring 2023 Volume 6 Issue 1 Contents
Partnership Powered Progress
We can help you achieve your goals working together to facilitate and deliver valuable advances in life science.

Aldevron has proactively invested in capacity expansions to ensure high-quality product with speed of delivery, all backed by unmatched industry experience and expertise.
We want to be your partner of choice providing plasmid DNA, mRNA, proteins, and other biologicals to support your work.
4055 41st Avenue South, Fargo, ND 58104 USA +1 (701) 297-9256 | +1 (877) 787-3362 a ldevron.com Supplying plasmid DNA, mRNA & proteins from research through commercial development
Since 1998, Aldevron has provided clients the integrated services they need to advance their discoveries.
The IBI editorial team again have curated a set of articles that indicate upcoming challenges of the pharmaceutical industry from smarter approaches to clinical studies to smart injection devices.
A challenge faced by the pharmaceutical industry is the high failure rate, of especially small molecule drugs, under investigation in proof-of-principle studies This is especially the case in so-called weak indications like CNS related diseases. Here there is a high risk that new drugs are deemed as inefficacious or not more efficacious than already marketed drugs. However, in these studies there might be patient collectives that show a significant improvement of their symptoms, while in most of the test group there is no improvement. By looking at the overall outcome, drug developers may conclude that the drug is not sufficiently efficacious and therefore discontinue the development of a certain compound, driving the cost of drug development on one hand and denying a sub-group of patients a possible lifechanging treatment. Ivano Lodato of Allos AI describes how smart statistics and machine learning may help to sieve through the mountain of data gathered in clinical trials. This may enable the identification of such sub-populations that respond to a treatment and maybe find a suitable biomarker(s) on the way.
The healthcare industry as a whole is faced with a shortage of skilled labor. This will increase as the baby-boomer generation gets older and with less healthcare professionals to administer care. Industry is developing solutions to make drug applications easier (faster) and less error prone for caregivers (professionals and next of kin) or enabling self-administration. For injectables, prefilled syringes (PFS) have been a real gamechanger offering ready to use drugs. The addition of so-called needle safety devices decreases the risk of injury and possible infection of caregivers. Robert Fielders at Recipharm gives excellent insight into all aspects of the PFS fill and finish process. As PFS increase the ease-of-use for caregivers, their use is limited for self-administrations of patients who are unable to handle syringes due to age or illnesses e.g., rheumatoid arthritis. For



IBI – Editorial Advisory Board
• Ashok K. Ghone, PhD, VP, Global Services MakroCare, USA
• Bakhyt Sarymsakova – Head of Department of International Cooperation, National Research Center of MCH, Astana, Kazakhstan
• Catherine Lund, Vice Chairman, OnQ Consulting
• Cellia K. Habita, President & CEO, Arianne Corporation
• Chris Tait, Life Science Account Manager, CHUBB Insurance Company of Europe
• Deborah A. Komlos, Senior Medical & Regulatory Writer, Clarivate Analytics
• Elizabeth Moench, President and CEO of Bioclinica – Patient Recruitment & Retention
• Francis Crawley, Executive Director of the Good Clinical Practice Alliance – Europe (GCPA) and a World Health Organization (WHO) Expert in ethics
• Hermann Schulz, MD, Founder, PresseKontext
• Jim James DeSantihas, Chief Executive Officer, PharmaVigilant
these cases we see an increase in the uptake of injection devices helping with the correct dosing and injection of drugs. Some of these systems have been on the market for decades. Michael Earl at Owen Mumford will share an insight into the future of smart and interconnected injections devices. Together with ever more sophisticated warble devices monitoring lifestyle and diagnostic parameters in real time, smart drug delivery devices offer a real improvement for many chronic diseases. Measuring low flowrates may be essential for future smart device developments but they are already in use to manage the complex manufacturing processes of novel therapeutics like cell-therapies. Nico Polley at SONOTEC GmbH explains what solutions technologies his company can bring to the table to measure and regulate low flowrates in bioprocesses.
As in the previous issues editions of IBI we continue with articles about the fast growing field of ATMPs. An editorial by Martín and Shushant Jain at Ncardia give a hopeful insight how disease models for neurodegenerative diseases generated from human induced pluripotent stem cells (iPSC) enable to study underlying molecular disease mechanisms. Aldevron describes the current developments in the analytical space for mRNA-based drugs. As this field is rapidly developing, we can expect to see the adoption of new analytical techniques into the regulated GMP environment.
This issue is wrapped up by an interview with Shawn Cain of PCI, gives a fascinating insight into the globally interconnected world of biopharmaceutical drug manufacturing.
Dr. Steven A. Watt, Head of Business Development at A&M STABTEST GmbH
• Jeffrey W. Sherman, Chief Medical Officer and Senior Vice President, IDM Pharma.
• Lorna. M. Graham, BSc Hons, MSc, Director, Project Management, Worldwide Clinical Trials
• Mark Goldberg, Chief Operating Officer, PAREXEL International Corporation
• Maha Al-Farhan, Chair of the GCC Chapter of the ACRP
• Rick Turner, Senior Scientific Director, Quintiles Cardiac Safety Services & Affiliate Clinical Associate Professor, University of Florida College of Pharmacy
• Robert Reekie, Snr. Executive Vice President Operations, Europe, Asia-Pacific at PharmaNet Development Group
• Stanley Tam, General Manager, Eurofins MEDINET (Singapore, Shanghai)
• Stefan Astrom, Founder and CEO of Astrom Research International HB
• Steve Heath, Head of EMEA – Medidata Solutions, Inc

4 INTERNATIONAL BIOPHARMACEUTICAL INDUSTRY Spring 2023 Volume 6 Issue 1
Foreword






PHARMACEUTICAL INDUSTRY 5 www.international-biopharma.comEmail: sales@lifesciencegroup.co.uk Telephone: +44(0)1234889180 CellCultureProducts forHumanCellandGeneTherapy ManufacturingCapabilities forBespokeMediaProduct Wecustommakemedia,buffersandotherxeno-freeproductstogive youthesolutionthat’srightforyou. Ourproductscanbeusedforresearchandbio-productapplications.Our expertisesmoothsthetransferofprocessesandsuccessfulscale-up. Ourproductsinclude: •CellShip® •T-Store® •CellSplit® •CellCultureReagentProduction •CellCultureMediaDevelopment andOptimisation •KitManufactureandAssembly •BulkProduction •HumanPlateletLysate •HumanABSerum •HumanSerumAlbumin(HSA) ContactUs
Global Sterile Manufacturing and Lyophilization Capabilities of Large and Small Molecule Biologics –PCI Shows the Way
PCI’s global manufacturing capabilities are in complex formulations, high potency, and lyophilization and your capabilities cover a broad range of injectables including nanoparticles, mRNA, mAbs, proteins, oligonucleotides, and other biologics across multiple delivery formats.
Q: Can you please share any specifics about PCI's sterile fill-finish achievements so far?
A: At the end of 2021, PCI Pharma Services acquired Lyophilization Services of New England, Inc. (LSNE), expanding PCI’s breadth of services as a global CDMO, building on our expertise in specialty drug product manufacturing and packaging at both clinical and commercial scale. Already perceived as a pioneer in the packaging of biologics, the addition of LSNE cements PCI’s reputation as a leading global CDMO, providing an integrated solution to clients across the entire drug product lifecycle from sterile development to commercialisation, meeting the demands of the ever-growing biologics market and bringing life-changing therapies to patients faster.
Our company culture, employees and processes are fully aligned to our strategy of focusing on our customers and the patients that they serve. Providing an all-encompassing streamlined sterile supply chain, many of our clients are leveraging the benefits of mitigating distribution and handling risks of their valuable biologic therapies as our sterile fill-finish manufacturing facilities are located within close proximity to our biotech packaging centres of excellence. Both of which, continue to grow with significant resource investments in terms of manufacturing and packaging processing technologies, in-house analytical laboratories and temperature-controlled storage and distribution capabilities.
Most recently, our sterile fill-finish and lyophilization facility in Madison, WI received its first commercial approval from the FDA. This now makes five commercially approved manufacturing facilities in our global network, with another four manufacturing sites coming online in the next year extending our global reach and capabilities further.
Q: How do you differentiate PCI Pharma Services from other CDMOs in the biologic market?


A: PCI continues to grow and evolve and as a fully integrated global CDMO, we are truly spanning the drug product lifecycle, connecting development and commercialisation, de-risking the supply chain and delivering true speed to market on behalf of our clients. We are a strategic partner and an integral part of the supply chain as the bridge between life-changing therapies and patients. Our expertise combined with innovative technologies means we deliver more than just a service, we are a trusted partner sharing an industry-leading depth and breadth of knowledge.
As part of the ongoing evolution of PCI and by listening to our clients, we are proud to introduce speed solutionsTM to the market. Providing the ultimate in solution flexibility and complete customer-centricity, speed-solutions combine value-added services and expertise, delivering an integrated approach to every client project, de-risking their supply chain by eliminating the need to transfer services such as packaging design and artwork to alternative suppliers as well as providing expert regulatory and clinical support services. Irrespective of where our clients enter the PCI world, they are supported with the option of an end-toend solution both within specific phases of the product’s lifecycle and across their development to commercialisation journey.
Differentiating what we do, PCI Pharma Services is commitment to and invests in digital transformation utilising innovative technology. One such platform is pci | bridgeTM which complements our project management capabilities by creating efficient and uncomplicated ways of working together.
This industry-leading digital customer platform provides our client partners with real-time insights into their portfolio of work at our sites around the globe, unlocking productivity with access to real-time supply chain information and digital workflows.

Q: PCI’s journey into sterile fill-finish and lyophilization is very prominent. What led to the decision to enter this field?
A: PCI Pharma Services has been an industry leader in providing specialist biologic packaging solutions from our global centres of excellence for many years. As a company driven by innovation and a wish to meet the needs of our client’s, investing in sterile fill-finish manufacturing capacity and capabilities to complement our existing packaging expertise was a natural progression in our journey to deliver an integrated end-to-end solution. Our sterile development and manufacturing capabilities have been built upon the foundations of the recently acquired Lyophilization Services of New England, Inc. (LSNE) with significant further investments planned. As the name suggests, LSNE was an industry pioneer in the service provision of expert sterile fill-finish and lyophilization solutions, especially on the larger scale.
We continue to see a growing demand for lyophilization manufacturing technology in support of parenteral products. The boom of biologics versus small molecule pharmaceuticals has also impacted the traditional approach for sterile fill-finish services. Due to the stability challenges seen with many biologics, lyophilization is essential to improve product stability and reduce the complexity associated with cold chain logistics. Large molecule products such as monoclonal antibodies and fusion proteins are perfect examples of the challenges involved in liquid presentations that lack stability and require specialist cold chain packaging, storage and distribution solutions.
With over 25 years’ experience in lyophilization and sterile fill-finish manufacturing and the specialised packaging of
6 INTERNATIONAL BIOPHARMACEUTICAL INDUSTRY Spring 2023 Volume 6 Issue 1 Talking Point
biologics, PCI has developed industry leading technical expertise in the end-to-end processing of these often challenging and complex molecules. We truly support full product lifecycle management from formulation and lyophilization cycle development through clinical to commercial packaging, labelling, and distribution with phase appropriate processing and analytical/ microbiology testing.
Q: How will PCI respond to the increasing market demand for sterile fill-finish?
A: As part of our global strategy to increase our sterile fill-finish capabilities and capacities, and to address the ongoing global capacity shortage, PCI is continuing to build on its current capabilities to assist both existing and new clients in drug development and manufacturing.
With recent successful FDA inspections and larger scale manufacturing investments, both our Madison and Bedford facilities can provide flexible commercial solutions for our clients. At Madison, Wisconsin, we recently added an additional large-scale lyophilizer, now doubling our initial capacity and we are expanding our presence in New England with a $100m investment in a high-throughput commercial facility on our Bedford, New Hampshire campus. This investment supports the construction of a new 57,000ft2 facility expansion, enhanced capabilities and increased capacity all using state-of-the-art isolator technology including high speed, large volume sterile fill-finish lines with the capacity to fill 400 vials per minute and auto-loading twin 40 square meter lyophilizers.
We have also further invested in industry leading robotic technology to complement our existing global sterile fill-finish capabilities. This investment comprises two robotic Cytiva Microcell Vial Filler units supporting clinical scale manufacture, one located in San Diego, California and one in Melbourne, Australia. In addition, a large-scale Cytiva SA25 Aseptic Filling Workstation, also located at our San Diego facility, allows us to deliver a seamless, end-to-end, sterile fill-finish solution across multiple dosage forms including vials, prefilled syringes and cartridges, with flexible small to large-scale production capabilities meeting the bespoke needs of our customers.
These advanced robotic technologies provide advanced methodologies of improving efficiency, reducing cost and increasing sterility assurance, and are gaining huge popularity for the primary filling of Ready to Use (RTU) containers such as vials, syringes and cartridges. They have successfully completed final stages of validation and are fully operational.
Q: What do you foresee for oligonucleotide and mRNA therapeutics?
A: Oligonucleotides and mRNAs have been the fastest growing market segment in the last 5 years. PCI has seen a tremendous rise in the number of our clients developing RNAi or siRNA products. With the clinical and commercial API of these drug types, as well as Oligonucleotide API, often extremely valuable and in very short supply, our clients benefit from our continuous drive for efficiency and focus on reducing line-loss, one of the major benefits of our robotic aseptic filling platforms.
We also work with a large number of lipid nanoparticle (LNP) formulations, a common formulation technology used in mRNA based therapeutics and vaccines. The processing and lyophilization of LNPs involves great expertise, as lipids in the LNP may be difficult to reconstitute without the experience of a lyophilization development specialist.
The development of new Covid-19 vaccines and the emergence of mRNA therapeutics has created a market constraint on access to critical raw materials and technical expertise. At PCI, we have over ten years' experience in the development and manufacture of mRNA therapies, and together with our biotech packaging centres of excellence, our end-to-end solutions enable our clients to move their mRNA therapeutic from development to commercialisation and beyond.
Q: What capabilities are needed for today’s complex therapeutics?
A: Today’s drug products are increasingly varied with new break-through technologies being developed across a wide range of therapeutic classes. CDMOs must therefore meet the challenge by providing clients with a high level of expertise, such as the ability to formulate and fill a variety of complex processes, with scalable development and manufacturing solutions delivered in a quality-driven, cost- and time-efficient manner.
At PCI, we have noticed an increased demand for the formulation of Lipid Nanoparticles (LNPs), aseptic ball milling, self-assembling polymer particles for controlled release products, and APIs that require organic solvent lyophilization. The technical transfer to GMP manufacture of these complex processes can often require multiple engineering runs and process-specific media fill validation programs.
Where possible, CDMOs should use disposable product contact manufacturing materials, firstly to reduce the risk of any potential cross contamination, and secondly to eliminate the need for time-consuming and expensive cleaning procedures and validations. The product lifecycle stage should also be considered to ensure that any processes or analytical methods are developed to the appropriate validation requirements. The engineering team should ensure the aseptic process is scalable and will maintain compliance through the development stage to commercial manufacture of the product, as these complex products require strong process engineering capabilities.
To meet the demands of a dynamic marketplace, CDMOs need to be collaborative and creative, with the ability to provide their clients with a tailored service. Whether it be for complex formulation process development, scale up, technology transfer or bespoke packaging of biologic drug products, this approach allows CDMOs to deliver flexible, agile and timely solutions to help bring life-changing therapies to patients.
Q: Can you share some innovation used for your Sterile Manufacturing Programmes?
A; Utilising the latest advancements of the robotic Microcell and SA25 technologies, PCI delivers flexible aseptic fill-finish solutions for both small and large-scale production across a variety of dosage forms including vials, prefilled syringes and cartridges for use
INTERNATIONAL BIOPHARMACEUTICAL INDUSTRY 7 www.international-biopharma.com Talking Point
in auto-injectors, helping to meet our clients’ scalable aseptic manufacturing needs, delivering products to patients safely and efficiently.
The addition of these innovative robotic aseptic fill-finish platforms at our San Diego, US and Australian facilities enhances our renowned global sterile and lyophilization capabilities. These advanced technologies not only expedite the filling process with automation, but enable us to pivot between filling multiple dosage formats, bringing even broader sterile fill-finish solutions to PCI clients across the entire drug product lifecycle allowing therapies to be brought market with increased speed and safety.
A key advantage of working with PCI is our high level of technical expertise. Current innovation in the vaccine space has placed tremendous strain on the manufacture of sterile filters and their supply chain, resulting in lead times of 50 weeks or longer in some geographies. A prime example of our client and innovative focus is when faced with filter procurement challenges, our in-house expert engineering team found the same membrane could be used in different filter housings – and then designed the interfacing gamma irradiated tubing sets to allow us to use the new filter within the customer’s process following validation. In short, we think outside the box to keep supply chains moving to ensure we meet client and patient needs. We are proud to say that time and time again, as in this example, our creative teams turn problems on their heads and find solutions!
Q: PCI has the capability to support any stage of a “Sterile fill-finish project” Can you briefly explain to our readers, what process you follow when working with challenging formulation processes?
A: At PCI, we employee formulation subject matter experts across our global manufacturing network and ensure relevant expertise is assigned to every client project. We also boast the necessary state-of–the-art equipment and in-house analytical capabilities to support these more challenging formulation processes. Applying Quality by Design principles, we have the ability to establish critical product temperature attributes using tools such as scanning, DSCs and freeze dry microscopy to ensure project success. These in-house capabilities allow us to reduce suspensions, time release formulations, etc. to practice.
If there is a particularly challenging formulation, our network of scientists work together to develop the required solutions. From the handling of liposomes to designing 100% aseptic formulations, we have the experience and expertise to deliver life-changing therapies to patients.
Q: PCI are experts in packaging capabilities relating to biologically derived products. Can you explain what the current market demand in this area is, and how you are meeting industry needs?
A: With the pharmaceutical industry’s growing pipeline of biologics, the need for technically advanced manufacturing and specialised packaging support has grown considerably. Committed to being a market leader in the packaging of biologic products for our global clients, our goal is to help our customers safely and efficiently bring their novel medications to patients. With more than five decades in the healthcare services business, 20 plus years of which have been in biologics, and delivering over 90 successful product launches each year, PCI has developed
industry leading technical expertise in the end-to-end processing of these often challenging and complex molecules. Our industry insights and expertise enable us to provide biologic packaging solutions that truly differentiate products.
Driven by innovation and the trend towards self-administration and patient-centricity, we offer advanced, flexible packaging solutions for a diverse portfolio of conventional and specialty injectable drug delivery devices. We have the flexible scalability to handle the dynamic volumes of biopharmaceutical therapies, whether large or small, from niche personalised medicines to large-volume treatments.

Complementing our sterile manufacturing investments, we continue to expand our European, North American and UK biotech Centers of Excellence for clinical and commercial packaging. These state of the art facilities are equipped with advanced packaging technologies for the labelling and assembly of vials, cartridges, standard prefilled syringes, advanced safety syringes, autoinjector and pen devices complete with integrated top-load Dividella cartoning and in-line serialisation.
Partnerships with leading suppliers such as Dividella, Groninger, Marchesini Group and Syntegon (formerly Bosch Packaging Technology) and investments in the latest high-speed automatic packaging technologies allows for greater flexibility in serving our customers across their clinical and commercial supply-chain requirements for global clinical trials, product launches, global ramp-up, or ongoing market supply.
Meeting the dynamic demands of the marketplace whether it be for sterile process development, scale up, technology transfer or bespoke packaging of biologic drug products, at PCI we provide a collaborative, creative and tailored approach to deliver upon our mission of being the bridge between life-changing therapies and patients. By combining our expertise in sterile fill-finish manufacturing with specialist biologic packaging, labelling and cold chain distribution provides a valuable end-toend solution, simplifying the supply chain while delivering time and cost efficiencies.
Shawn Cain
Shawn Cain is currently the SVP at PCI Pharma Services, a pharmaceutical full service CDMO. Mr. Cain has over thirty years of experience in combining process engineering and project management to direct the development and manufacture of sterile pharmaceuticals, cell-based biologics, and medical devices. Most recently he was the COO of LSNE, which was acquired by PCI. Mr. Cain also worked at Organogenesis and was the Director of Operations for another pharmaceutical CDMO, Formatech, Inc. Prior to that, he was Interim President and Chief Executive Officer of Arbios Systems, Inc. Previously, Mr. Cain was employed at Becton Dickinson’s Biologics Business. Mr. Cain was also the Vice President of Operations for Circe Biomedical, Inc., where he led the development of the bioartificial liver technology. Mr. Cain holds six patents, received his M.S. degree in Biological Sciences from the University of Massachusetts and a B.S. in Biological Sciences from Northeastern University.
8 INTERNATIONAL BIOPHARMACEUTICAL INDUSTRY Spring 2023 Volume 6 Issue 1
Talking Point
Lyophilization and Sterile Manufacturing
Driving development and connecting commercialization of sterile and lyophilized drug products, we are dedicated to your success in bringing life-changing therapies to patients.


www.pci.com
OUR END-TO-END BIOLOGIC SOLUTIONS INCLUDE:

• Sterile Formulation & Lyophilization Cycle Development
• Lyophilization and Sterile Fill-Finish Manufacturing
• Aseptic Robotic Technologies
• Analytical Support
• Clinical & Commercial Labeling & Packaging
• Refrigerated/Frozen Storage & Distribution
talkfuture@pci.com
INTERNATIONAL BIOPHARMACEUTICAL INDUSTRY 9
Your sterile drug product destination. Our world.
High Accuracy Flow Meter for Low Flow Measurements

With the growing popularity of micro-bioreactors, perfusion, as well as cell & gene therapy applications in the life sciences industry, the need to measure low flow rates non-invasively is ever increasing. The new SONOFLOW CO.55 V3.0 non-contact clamp-on flow meter pushes the boundaries of low flow measurement in flexible tubing.

During the development of the SONOFLOW CO.55 V3.0 flow meter, SONOTEC focused on major requirements in the biotech industry that cover low flow applications in process development, cell & gene therapy, as well as accurate dosing of biopharmaceuticals. With the new sensor generation, SONOTEC offers outstanding measurement accuracy combined with excellent clamp-to-clamp repeatability. Designed to increase efficiency and reproducibility in PAT-related bioprocessing, real-time data availability makes the sensor also ideally suited for process modelling.
As a critical process parameter (CPP) the flow volume of the medium can affect critical quality attributes (CQAs), which are defined to ensure the desired product quality. Even minor deviations in the flow velocity or flow volume might have an effect on the cell growth. Thus, it is essential to measure the liquid flow in all process steps. Monitoring and validating real-time flow data throughout the entire production can substantially improve process stability.
Testing
In order to demonstrate the low flow capabilities of the new SONOFLOW CO.55 V3.0 flow meter series, the ultrasonic specialist SONOTEC performed a number of comparative measurements between a SONOFLOW CO.55 V2.0 and SONOFLOW CO.55 V3.0 sensor. For the testing, water (@ 23 °C) was pumped through a ¼” (OD) tubing using a peristaltic pump or a syringe pump, which are both connected via a Y-connector to the measuring tubing. Each pump can be pinched off using standard hose clamps. Both flow meters are clamped to a new, straight line of tubing with a distance of exact 20 cm before, between, and after the sensors. For accurate reference measurement, the scale does not have any contact with the setup material and is tared before each test run.

The plot summarizes the results by focusing on the flow range between 2.5... 100 mL/min. At flow rates higher than 50 mL/min, both non-contact clamp-on flow meters show almost the same deviation from the target flow with an accuracy of 1 % and better.
® CO.55 / 0250 V3.0
3 Measurement tubing
Masterflex® Platinum Cured Silicone 96410-16
4 Scale Sartorius Entris® 2202–1S
5 Syringe pump (≤ 100 mL/min) Chemyx Fusion 100T
6 Peristaltic pump (> 100 mL/min)
Masterflex® L/S® Thermo Scientific Masterflex® P/S Easy-Load II Pump Head (Model 955-0000)
10 INTERNATIONAL BIOPHARMACEUTICAL INDUSTRY Spring 2023 Volume 6 Issue 1
Application Note
List
SONOFLOW CO.55 V3.0 clamp-on flow meter with tubing No. Description Specification
Flow sensor A SONOFLOW® CO.55
V2.0 SN10709
SONOTEC Testing set-up
of Materials
1
/ 060
B SONOFLOW
SN10031
2 Flow sensor
Thermometer Fluke 52II
Medium Tap
de-gassed,
Density 0.9975 g/cm³
7
8
water,
23°C,
Testing of SONOFLOW CO.55 V3.0 and SONOFLOW CO.55 V2.0 in low flow measurement
The total testing in the low flow ranges covers 11 target flow rates with 5 runs per target rate. The X-axis indicates the flow rates as a logarithmic function. The red-dotted curve shows the mean values of the measurements with long-term successful SONOFLOW CO.55 V2.0; the blue-dotted curve depicts the mean values for the measurement with latest generation SONOFLOW CO.55 V3.0. The colored areas next to the dotted curves displays the standard deviation for the tested flow rate.
The plot impressively shows the improvements of the SONOFLOW CO.55 V3.0 flow meter compared to SONOFLOW CO.55 V2.0 in the very low flow ranges. Particularly in the range lower than 40 mL/min, the new ultrasonic sensor demonstrates its strength. Specifically designed for low flow applications in biopharmaceutical process development, the latest ultrasonic flow meter SONOFLOW CO.55 V3.0 is significantly more accurate than the previous sensor by a factor of 2 considering the testing with 2.5 mL/min. “Our latest non-contact flow meter SONOFLOW CO.55 V3.0 combines accuracy and usability for low flow applications”, summarizes Nico Polley, Product Manager of the non-contact flow meter series SONOFLOW CO.55 at SONOTEC GmbH.

The exceptionally low standard deviation for the SONOFLOW CO.55 V3.0 underlines the high accuracy in the very low flow rates. At flow rates above 10 mL/min, the standard deviation is only ± 2% for the new sensor; SONOFLOW CO.55 V2.0 achieves this excellent low standard deviation at a flow rate of 30 mL/ min.
Conclusion
For the flow rates between 5 mL/min and 20 mL/min, SONOFLOW CO.55 V3.0 shows a higher accuracy compared to SONOFLOW CO.55 V2.0 with a factor of 1.5. Although SONOFLOW CO.55 V2.0 is considered one of the most accurate non-contact clamp-on flow meters, the new sensor has been considerably improved for these flow rates.
The measurement results demonstrate that the development work for the SONOFLOW CO.55 V3.0 flow meter was successful and the goal of achieving significant improvements in the low flow ranges have been impressively reached.

Nico Polley
Nico Polley, born in 1980, is Product Manager of the non-contact flow meter series

SONOFLOW CO.55 at SONOTEC GmbH. In the Business Unit “Non-Invasive Fluid Monitoring”, his main focus is the development and marketing of the ultrasonic clamp-on sensors in the global bioprocessing market. He holds a diploma in economics from the MartinLuther-University Halle-Wittenberg. Before he joined SONOTEC, Nico Polley worked for KME, which is one the world’s largest manufacturers of semi-finished copper and copper alloy products. At KME, he was Team Leader Internal Sales before he got appointed Product Manager for strip products.
Contact:
SONOTEC GmbH
Nauendorfer Str. 2, 06112 Halle (Saale), Germany
Phone: +49 345 13317-0
Email: sonotec@sonotec.de Web: www.sonotec.eu
INTERNATIONAL BIOPHARMACEUTICAL INDUSTRY 11 www.international-biopharma.com INTERNATIONAL BIOPHARMACEUTICAL INDUSTRY 11 Application
Note
SONOTEC presents its SONOFLOW CO.55 V3.0 at the INTERPHEX from 25th to 27th April 2023 in New York, USA. Meet the SONOTEC team at booth 2801.
Generating Powerful New Pharma Insights from Graphs
Neo4j’s Alex Jarasch explains how knowledge graphs can be a valuable asset for the pharmaceutical industry to extract insights from complex data.
An interesting possibility is emerging for the life sciences industry – can we use a new approach to organising complex data to gain a more holistic view of the underlying problems we want to address?
The new approach is knowledge graph, which is defined by the AI research group The Alan Turing Institute as capturing information about entities of interest in a given domain or task (like people, places or events) and finding the connections between them.
Tackling the Hard Bio Problems
A knowledge graph is a type of data structure that represents information as a set of entities and the relationships between them. It is a way to organise and link data together in a way that is more easily understandable and accessible. The main feature of knowledge graphs is that they allow for complex connections between different data sources, which can reveal new insights and relationships that would be difficult or impossible to uncover using traditional SQL databases.
Knowledge graphs are multidimensional and can represent data in a variety of forms, including text, images, and structured data. This allows them to store and link together different types of information, such as scientific research, clinical trial data, and market data. The ability to make connections between different data sources is what makes knowledge graphs so powerful for the life sciences industry.
The first real-world use of graph technology that entered the public's consciousness was the Panama Papers scandal, where a network of journalists used graphs to link together millions of documents and uncover illicit financial activities. That seems at a remove from life sciences in one way, but in another it isn’t –both areas involve seeing useful patterns in a lot of what seems like “noise” to the average person.
In the field of biological science, for example, understanding the complex interrelationships between different factors, such as genes, environment, diet, and behaviour, is essential for gaining a deeper understanding of diseases and developing new treatments but is notoriously hard. Knowledge graphs could play a crucial role in aiding us here, by empowering analysis of these interrelationships and correlations on a large scale.
Modern native graph databases are particularly well-suited for this type of analysis. They are optimised for handling large amounts of interconnected data and so can store and link together billions of connections. That makes it possible to
analyse and make sense of massive amounts of data – important in fields such as medicine, where the amount of data being generated is growing rapidly, and traditional methods of data analysis are no longer sufficient.
The potential for using knowledge graphs in the life sciences industry is significant, but it’s still early days. While many pharmaceutical companies are already using knowledge graphs, the majority of these companies are only using them for a small portion of their database work. This means that there is a lot of untapped potential for using knowledge graphs to gain new insights and improve decision making in the industry.
The use of knowledge graphs in the life sciences industry has been primarily focused on three problems: identifying novel drug targets for new therapies, transforming clinical trials, and managing supply chains in a more dynamic fashion. As companies begin to use knowledge graphs to connect and analyse their data, they are hoping to find new ways to supplement these use cases and approach high throughput screening and compound registrations in more efficient ways.
Neo4j recently hosted an event to explore the possibilities of knowledge graphs in the life sciences industry. Participants shared a wide range of emerging use cases. An example was AstraZeneca's application of knowledge graph technology with chemical reactions to predict new reactions and molecular synthesis. This was to aid that AstraZeneca to discover new compounds and to improve the efficiency of the drug discovery process. Additionally, knowledge graphs are predicted to help AstraZeneca circumvent or attack existing patents by finding new ways to synthesize the same compound.
Graph Queries Execute 3,000 Times Faster than SQL
Another example that’s emerging as best practice is at GlaxoSmithKline (GSK), which is exploring the use of knowledge graphs to improve clinical reporting workflows. The traditional clinical reporting process can be labour-intensive, involving multiple handoffs and data transformations. GSK researchers found that by applying knowledge graph technology, they were able to overcome these challenges by creating a single, contextualised knowledge graph that can be used to streamline the process and make it more efficient. It was found to help reduce the time and resources required to complete clinical reports, and boost the overall accuracy and completeness of the data. In addition, by using a Graph Data Science library and out-of-the-box machine learning tools, GSK was able to process large amounts of data and extract valuable insights that can be used to improve the drug development process.
The use of knowledge graphs helps make sense of complex data and uncovers hidden patterns and relationships that would be difficult or impossible to find using traditional methods. One of the key advantages of knowledge graphs is that they are not dependent on data sources being prepared or formatted
12 INTERNATIONAL BIOPHARMACEUTICAL INDUSTRY Spring 2023 Volume 6 Issue 1
Regulatory & Compliance
CONTRACT DEVELOPMENT AND MANUFACTURING OF BIOPHARMACEUTICALS
Richter-Helm is a Germany-based GMP manufacturer specialized in products derived from bacteria and yeasts, with a proven 30-year track record.

Count on us to flexibly provide a comprehensive range of services and customized solutions. Clients worldwide have already benefited from our commitment to good manufacturing practice and total transparency. Our work focuses on recombinant proteins, plasmid DNA, antibody fragments, and vaccines.
Richter-Helm consistently works to the highest standards of pharmaceutical quality.
Contact us
+49 40 55290-801
www.richter-helm.eu
LEARN MORE ABOUT OUR SERVICES AND CAPABILITIES
13 INTERNATIONAL BIOPHARMACEUTICAL INDUSTRY Spring 2023 Volume 6 Issue 1
MICROBIAL
ARE YOU LOOKING
EXPERTS IN MEET US! ASGCT 2023 LOS ANGELES CONVENTION CENTER, US May 16 – 20, 2023
PRODUCTION?
FOR
in a specific way – in fact, they can work with any native data structure. Additionally, knowledge graphs allow for querying the data in a more natural and intuitive way, by asking meaningful questions rather than having to write complex SQL queries.
Another major advantage is raw processing speed. Queries can be performed much faster than traditional SQL databases –typically 3,000 times faster and across dense networks of knowledge. That means that in a clinical trial, a knowledge graph can be used to identify the best doctors to target for recruitment based on not only their area of expertise but other key metrics like current caseload, access to equipment, and whether they may be working with a competitor. This can help to increase the chances of overall trial success by only ever recruiting doctors who have the necessary expertise and resources.
It is becoming clear that knowledge graphs are particularly useful in the context of clinical trials, where the growing challenge of reaching statistical significance with data from small populations with rare conditions is becoming increasingly important. For example, in diabetes research, knowledge graphs can be used to map the phenotypes of mice and humans by linking together clinical parameters that are phenotypically equivalent. This can help researchers to identify and study new drug targets (in an animal model) and to better understand the underlying mechanisms of the disease.
There is no doubt that the future of the life sciences industry is increasingly data-driven. Pharmaceutical companies recognise
that data is a key differentiator and are investing heavily in data-driven approaches to improve operations and to determine product roadmaps more strategically and navigate regulatory approvals more swiftly.

The Pharma Sector’s Data-based Future
Currently, the challenge for life sciences companies is to be open to new data technologies and techniques and to understand the potential they offer in solving critical business challenges in innovative ways. Instead of relying solely on traditional relational database systems, companies should consider alternative approaches, such as knowledge graphs, to gain a more complete and holistic view of their operations and the market, leading to more informed decision making.
While it is important to focus on enriching and enhancing data, it is also important to recognise the potential of knowledge graphs to extract insights and make sense of large and complex data sets. The more data you feed into a knowledge graph, the more accurate the picture it is able to build, employing AI and machine learning algorithms to understand the insights that matter. A good analogy for this would be Google Maps, which builds reliable representations of the physical world from large volumes of diverse data. Even if your satnav makes some odd route choices now and then, the overall picture of reality it conveys remains accurate.
As the clinical opportunity for the pharmaceutical industry grows, it becomes increasingly demanding and complex in scope. Knowledge graphs could be a genuine game-changer, as they allow researchers to understand the value of relationships between data, which is as important as the individual data points themselves. Without the ability to mine those correlations for new insights, companies will lack vital context and find themselves compromised in their ability to make accurate advanced predictions.
It's becoming clear that as data becomes increasingly important for the life sciences industry, hiring data scientists and data administrators will be a high priority for the community going forward. Along with that growth in resources should be continued exploration of knowledge graphs and all they represent.
Dr. Alexander Jarasch

Dr Alexander Jarasch, the Technical Consultant for Pharma and Life Sciences at native graph database leader Neo4j. He was previously Head of Data Management and Knowledge Management at Germany’s National Center for Diabetes Research (DZD). He is a visionary speaker on the future of clinical investigation, plus AI and data management in the pharma and healthcare space – in particular the potential to advance pharmaceutical analytics and unlock terabytes of hard-to-parse research/trial data by revealing data relationships for better predictive accuracy.
Email: alexander.jarasch@neotechnology.com
14 INTERNATIONAL BIOPHARMACEUTICAL INDUSTRY Spring 2023 Volume 6 Issue 1
Regulatory & Compliance
The patient benefits of UniSafe® are:

• Passive needle shielding to help prevent needlestick injuries

• An unobscured syringe barrel for full drug visibility to create user confidence

• A large, ergonomic plunger head and a smooth finger flange, resulting in an integrated look and feel which provides reassurance
• Optional extended finger flanges for patients with strength and dexterity impairment (applicable to 1mL only)
• The same injection technique as a pre-filled syringe making it intuitive to use


• It cannot be reused or prematurely activated

INTERNATIONAL BIOPHARMACEUTICAL INDUSTRY 15 www.international-biopharma.com
UniSafe® 1mL proven, on market, in patient use 1mL & 2.25mL Spring-free passive safety devices for pre-filled syringes
UniSafe® is a registered trademark of Owen Mumford Ltd ©️ 2023 OMPS/ibi/ad/ob/0123/7 Want to know more? Visit ompharmaservices.com/ibi-march2023 or email pharmaservices@owenmumford.com
Causal Inference and the Future of Clinical Trials
Randomizing every non-essential variable in a scientific experiment to isolate only specific relations is the simple but powerful idea behind Randomized Controlled Trials (RCT). In practical applications however, RCTs have proven to be arduous to set-up and because of the stringent inclusion/exclusion criteria, their results are often plagued by bias and shallow statistical value. On the other hand, observational studies are easier to implement, but the statistical results inferred are also heavily biased, due to the lack of knowledge or understanding of the underlying relations between the relevant variables of an experiment, and even worse skewed by spurious correlations. Machinelearning and deep-learning algorithms are not exempt from such grave issues: they leverage quantity of data over their quality, introducing bias and fundamentally lacking explainability as expected by their black box nature. In the following, we introduce the framework of causal inference, which allows one to disentangle the interactions between variables of an experiment in terms of their cause-effect relations to produce a glass box of explainable results. As long as these interactions are known, even though not necessarily observed or quantifiable, the formalism allows one to answer interventional questions typical of RCT, e.g. “what happens if I increase the dose of the drug?”, leveraging purely observational data. Under stronger assumptions, questions aiming at uncovering the “why?” behind a specific mechanism can also be rigorously answered within the framework. Causal inference is thus not only a logical, human-centered approach to statistical problems but also the next frontier of intelligent data analysis in clinical and medical settings.
Clinical trials are typically designed so that the effectiveness of a treatment on a specific outcome, such as the improvement of symptoms can be assessed. Deceivingly simple, the process of obtaining unbiased and statistically significant results is far from straightforward. In fact, while correlations between treatment and outcome can be easily computed, in principle exist many factors that can influence the outcome and treatments at the same time, (heavily) affecting the result. These factors may be known, observed or not (i.e. data was or was not collected for that specific factor/feature), or even unknown to the experimenter, inevitably lead to biased estimates. To bypass this problem an experimenter would keep all these factors either static or completely random, so that if they do have any influence it is averaged out. Randomized controlled trials (RCT) of this kind are however very difficult to set-up: inclusion/exclusion criteria tend to be too-strict, patients drop out, discontinue or mix treatments; other times, the cohort of patients cannot be selected by the experimenter (e.g. Covid-19 pandemic) leading to biased samples. In these situations, observational studies are instead performed: raw data – with no further information about their mutual interactions – are statistically correlated and,
for instance, the effectiveness of a treatment on a symptom is evaluated.
Associative studies of this kind are currently underway all over the world, trying to find correlations between our favorite music and our favorite food, or whether a plant or an artificial chemical can have curative effects on certain patients. It is easy to imagine what an Herculean task it would be even for machines to sift through billions of numbers blindly, and more importantly how imprecise and uninspired the results one obtains may be. But the real dangers of correlation-based results derived from biased and small samples can be easily highlighted by the recent mistrust in children’s vaccines all over the world due to a single study with small number of participants that found a suspicious correlation between autism and vaccines, naively attributing vaccines as a cause of autism.1
One then may wonder whether it is even possible, starting simply from observational data to arrive at more precise results, while sidestepping the dangers of bias. In general, the answer is negative: even highly descriptive data, without the support of contextual information, may lead to false or plain wrong conclusions about the effectiveness of a treatment or the association between a drug and certain undesired symptoms. It must be noted that machine-learning and deep-learning, being types of algorithms which strongly leverage the correlative power of statistics, also possess the same weaknesses: they require huge amounts of data to give statistically significant results, and are inevitably biased towards results already present in the dataset. Luckily, to profoundly improve the results of a statistical study only one crucial step is required: the knowledge of the cause-effect relations between the variables in the systems, the foundation on which the difficult process of untangling the effects of variables rests on.
The Causal Graph
A causal graph consists of a set of nodes, each corresponding a variable in the dataset, and a set of arrows representing the parental relations of the nodes. For example, if a treatment (T) increases the white blood cell count (C), and decreases the inflammation (I), then the statement “(the value of) T causes (the value of) C and I” can be graphically depicted as in Figure 1.
16 INTERNATIONAL BIOPHARMACEUTICAL INDUSTRY Spring 2023 Volume 6 Issue 1
Regulatory & Compliance
Figure 1: A simple chain of cause-effects relationships between a treatment T and the outcomes I and C
C G A V E I T PEER REVIEWED
Figure 2: The causal graph involving vaccines and autism, with the dashed arrow representing the testing hypothesis that vaccines cause autism
Although the exact mathematical relations between an increase in treatment and the decrease of inflammation may be unknown, the existence of a causal relation (represented by the arrows) is sufficient to “connect” two variables, generally implying some interaction often underestimated/overestimated in a naive correlation study. Going back to the example of correlation between vaccines and autism, there may be a number of yet-unknown variables causing autism (A), like genes (G), and vaccines (V) may cause a number of known and unknown effects (E). The question is: does a cause-effect relation exist between vaccine and autism? Vaccines have been administered to children uniformly (hence, autism does not directly causes the decision of vaccinate a child), so really the question becomes: do vaccines cause autism? The situation is illustrated graphically in Figure 2. Of course, when one considers a less-biased and larger group of people, statistical analysis of data compared to the (in)dependencies between nodes implied by the above graph leads to the conclusion that NO such arrow exists, namely vaccines and autism may be spuriously correlated but they are NOT causally related. Hence causal graphs encode complex and intricate relations, which can then be constrained by comparing with real-world data. Following this procedure one can ascertain the existence, as well as the direction of a cause-effect relation between two (or more) variables. This is the first layer of causal reasoning: causal discovery.
Causal Reasoning: Interventions and Counter-factuals
The point of a clinical trial is to try and define the limits of usability and effectiveness of a drug, hence to predict the effect of external actions on the drug itself. In an ideal clinical trial, the treatment and its doses/duration are decided by the experimenter following a precise protocol, and are not influenced by any other factors, like pain, age, comorbidities, etc. We then say treatments are fixed, or intervened on, and the act of fixing its value is called intervention. Observational studies instead do not represent any external interventions from the experimenter who instead passively collects the data, or administers the treatments and doses on a case-by-case basis. The relevant point is that by intervening on a variable, we fix its value regardless of the actual causes that would naturally affect the value of the variable: hence intervention on a variable X is represented in a causal graph G by removing all arrows incoming into X, creating the mutilated graph G'. The use of 3 simple rules, collectively named do-calculus (as in, do an action, or intervene), applied on G', leads then to the unbiased estimation of the statistical effect of an intervention on X. Queries like “Would the symptoms reduce further if I increase the dose two-fold?”, “Would adverse effects start if I increase the drug dose?” belong to the second layer of causal reasoning: interventions.

To exemplify the above discussion, the aim of clinical trials is to determine the ACE of a treatment T on an outcome O, defined as the difference between the probability of the outcome O when the treatment has been fixed by the experimenter (“do T”) to the value T = 1 (treatment administered) or T = 0 (control group).
a variable does not correspond to a simple observation of the variable. To give a couple of simple examples, let us assume that a treatment T has a causal effect on an outcome O and now take two different cases: the treatment T causes changes in the variable F which in turn changes O, or F is the common parent of treatment and outcome. The situations are illustrated in Figure 3. Now the effect of interventions is not visible in the first graph (as no incoming arrows in T exist), and in fact the ACE can be written simply as:
ACE (O,T ) = P (O|do T = 1) − P (O |do T = 0 ) (2) = P (O|T = 1) − P (O |T = 0 ) (3)
The rules of do-calculus allow to simplify the above expression and write it in terms of data collected during observations. Indeed, situation arise whereby a simulated intervention on
INTERNATIONAL BIOPHARMACEUTICAL INDUSTRY 17 www.international-biopharma.com
Regulatory & Compliance
Figure 3: F is a child (left) or a parent (right) of the node T
ACE (O,T ) = P (O |do T = 1) − P (O |do T = 0 )
T T O O F F
where the interventions of the treatment can be without problems treated as observations (the data present in the observational dataset). On the other hand, the ACE for the graph on the right is quite different:
Intervention of the treatment interrupts the cause-effect arrow incoming from F , so that observing the variable treatment is quite different (in this graph) from intervening upon it. Now the result for ACE depends also on the variable F and is averaged over it. More complicated graphs exist and the effect of interventions on their variables may be more cumbersome to extract, but the formalism is rigorous, allows for unbiased results and needs less data to be trained, as the field knowledge required to draw the causal graph compensates for it.
There also exists a third and most powerful layer to causal inference, dubbed counter-factuals. Its goal is to answer hypotetical questions of the kind: “What would have happened if...?”, “Why?” from observational data. Indeed, if the mathematical relations represented by directed parentchild arrows are known (e.g. an increase of 20% of the dose of treatment improves the symptoms by 5%, a 40% increase by 15%, etc), we could in principle generate data which have not been observed during an experiment with ease: we create a perfect copy of our world in which one or more events have happened differently, and answer interventional questions in that world. Even though the knowledge of such precise relations between any medical variables is nowadays limited at best, simple counter-factuals scenario can be constructed and solved using the formalism of interventions described above.
It is perhaps curious to notice how intuitive the arguments given here may look. It is not an accident, as every human
being and most living organism are inexorably linked to the concept of evolution in time, and the cause-and-effect chain. Inevitably, it is very common to have asked or answered questions of the interventional type – ‘What happens if I..”or of the counter-factual type – “What would have happened if I...?”. Causal inference is then the mathematical formalism through which such complex, human-centred questions can be answered without bias and in a purely explainable way, the gold-standard of clinical and medical (AI aided) data analysis.
REFERENCES

1. A.J. Wakefield at al, RETRACTED: Ileal-lymphoid-nodular hyperplasia, non-specific colitis, and pervasive developmental disorder in children, The Lancet 351 (1998), no. 9103, 637–641, https://doi.org/10.1016/s0140-6736(97)11096-0
Ivano Lodato is an Italian born multidisciplinary researcher. He has received two master degrees in Physics in 2010 (University of Catania; Utrecht University), and has been awarded a PhD in theoretical physics from Utrecht University in 2014. He has worked in Universities and Research Institutes all- over the world, building a wide net of successful and specialized collaborators in Europe, India, China, US and Canada. His research interests span from network theory and interacting complex systems to causal reasoning applied to real-life systems, data sciences and artificial intelligence as well as branches of a more theoretical nature (number theory, black holes, quantum information theory) . Since 2022, he is a Founder and Chief Scientist at the health-tech company Allos AI, based in the UK.

18 INTERNATIONAL BIOPHARMACEUTICAL INDUSTRY Spring 2023 Volume 6 Issue 1 Regulatory & Compliance
Ivano Lodato
ACE (O,T ) = P (O|do T = 1) − P (O |do T = 0 ) (4) = P (O|T = 1,F ) P (F ) − P (O |T = 0,F ) P (F ) (5) F F
Advancing Patient Possibilities With Integrated Trial and Lab Services
Lab Services Include:
• Central Lab Services — Custom Kitting, Global Sample Logistics, and Storage
• Global PBMC and Clinical Sample Processing
• Extensive Pathology Curated Biospecimen Inventory
• Immune Monitoring Solutions at Any Scale

• Advanced Tissue and Liquid Biopsy Profiling
• Genomics Services
• Bioanalysis of Large Molecules, Complex Biologics, and Advanced Therapies
• Biomarker Data Management
Trial Services Include:
• Clinical Development Planning and Consulting
• Biomarker-driven Clinical Trial Strategy and Execution
• Design of Analytical and Clinical Studies
• Companion Diagnostic Development and Go-To-Market Strategy
• Regulatory Affairs Strategy and Consultancy
• Decentralized Clinical Trial Solutions
• Complex basket, Master protocol, and Umbrella Trial Management
• Relationships with Key Academic Centers via the Precision Site Network
AT PRECISIONFORMEDICINE.COM
VISIT US
The Future of the Connected Drug Delivery Device Market: Key Areas for Innovation
The past two decades have seen huge growth in the market for injectable drug delivery products; this shows little sign of slowing down with a further 9.1% of annual growth predicted until 2030.1 Biotherapeutics have played a significant part, with biologics and biosimilars mostly administered via subcutaneous injection. With a growing number of biosimilars set to come onto the market (more than 30 biologics will lose exclusivity in the US alone between 2023–20282), we are likely to see the market for subcutaneous drug delivery devices develop further.
As the market gets more crowded, manufacturers of both biologics and biosimilars can differentiate from competitors through the device itself. One area of focus is digitalisation: connected drug delivery devices which capture a variety of data related to drug administration, are becoming increasingly sophisticated, by providing step-by-step guidance to patients, for instance. There is great potential for these devices to improve patient care, particularly as treatment and drug administration are increasingly taking place outside of a hospital setting.
Given the increasing shift towards self-administration, creating connected drug delivery devices that are intuitive and easy to use is also a necessity, and will in turn help to improve treatment adherence. Moreover, as we continue to see growth and innovation within the industry, more benefits are emerging for both patients and healthcare professionals. This article will draw on our own research here at Owen Mumford Pharmaceutical Services, as well as discussions with industry experts, to analyse key trends that are set to shape the connected device market in the coming years.
Optimal Device Choice and Adaptability
Evolution in the connected drug delivery device market has led to a number of different device variations and therefore options for pharmaceutical companies. Reusable devices may be prioritised by pharma companies due to their reduced cost and environmental impact compared to single-use devices. Yet, single use devices may be more appropriate for certain less frequent therapy regimens or specific patient groups due to their small size and convenience. Additionally, from the device manufacturers’ perspective there is the choice between creating new devices that integrate connectivity features from the earliest stages of development, or adding connectivity to an existing product on the market.
Opinions on optimal connectivity features are shifting often in line with the evolution of wireless technologies and the performance of electrical components. Likewise, changes to regulations can see the commercial arguments on the most suitable device choice evolve as well. One example is the FDA’s guidance on cybersecurity in medical devices which was updated in 2018 and then again in 2022 due to the speed of change in
this area.3 The guidance provides recommendations on secure design, labelling, and the documentation to include in premarket submissions for devices with cybersecurity risk. The need to meet these requirements makes the selection of a reliable and supportive device partner doubly important.
As regulators become stringent, manufacturers will need to consider the additional resources that may be needed to compile robust submissions. Pharma companies must also take into account differences in regulatory and environmental standards between geographic markets. In the EU, for instance, medical devices with an electronic component are subject to the directive on Waste from Electrical and Electronic Equipment (WEEE),4 which encourages reuse and recycling to reduce waste.
All these competing factors mean that pharma companies are predominantly looking for flexibility and options from their device selection. Platform devices which are able to adapt to the needs of different patient groups, geographical market, therapies or drug formulations with limited design modifications are often the preferred option. As device development continues, patients are likely to be met with a growing variety of product designs in the coming years – allowing individual patient groups to find the device that best fits their own requirements.
Improving Usability for Patients
Improved user experience is a key benefit required with connected drug delivery devices. With a better and potentially simpler injection experience, patients are more likely to continue using a product consistently, ultimately generating improved treatment adherence rates. Connected devices can help to improve the patient experience by providing real time, in-use feedback to patients throughout the injection process. With these features, users receive step-by-step instructions and guidance at every stage of the injection process, helping them to build confidence and reduce the risk of errors during drug administration.
Additionally, notifications, often via an associated app can help remind patients when their next dose is due and alert them if they miss one. With trends moving towards formulations that need to be administered less frequently, these features are especially important. With longer gaps between injections, patients are likely to require additional support when undertaking treatment. Training devices with sensors to assess if a patient is using a device correctly and that provide more specific guidance may also encourage patients to switch to a connected device, and give confidence to those who are switching devices or self-administering treatments for the first time.
Continued innovation in the connected device market will also lead to simplified data collection. Currently, patients who use connected devices are recording key injection information such as the time, date and dosage administered in a secondary device or application. With 5G, however, connected drug delivery
20 INTERNATIONAL BIOPHARMACEUTICAL INDUSTRY Spring 2023 Volume 6 Issue 1 Research / Innovation / Development
PEER REVIEWED
devices will be able to send injection data directly to the Cloud without the need for a secondary application, though patients can still use them to monitor treatment more closely if they wish. Removing the necessity of a secondary device is also likely to encourage the use of connected drug delivery devices among an older, less tech savvy, segment of the population. As data integration improves, we may see an increasing number of digital health apps that provide a valuable supplement to patient treatment and allow for more personalised therapies and holistic view of the patient.
Data Integration in the Healthcare Sector
Currently, healthcare systems are lacking data integration and interoperability – the ability of different information systems, devices and applications to connect and share data in an effective way. Connected device data is not being adequately combined with other sources – such as electronic patient health recordsto develop a more complete view of an individual patient. This makes it difficult for healthcare professionals to act on real time data or decide on appropriate interventions and therefore may limit the effectiveness of remote treatment monitoring and care.
One of the key difficulties that must be overcome to better integrate connected device data into the healthcare setting is the distinct differences in privacy laws across the world. Laws in Europe, for instance, are highly fragmented, both at the national and regional level, creating challenges for companies launching their connected devices across different markets. As well as navigating various privacy laws, pharma companies must assure patients wary of the security of their data that it is being suitably protected.

The latter concern has led to the incorporation of user authentication steps. However, this might add complexity for the patient, so it is crucial to ensure devices are still easy to use, to allow for widespread adoption. Limited data access and integration may also be hindering efforts by healthcare providers to create new services and business models based on the data generated from connected devices. As data from connected devices becomes more accessible, there are exciting areas for development that will benefit both patients and healthcare professionals.
Data for Device Improvements
Outside the healthcare setting, the wealth of data which can be

INTERNATIONAL BIOPHARMACEUTICAL INDUSTRY 21 www.international-biopharma.com Research / Innovation / Development
collected will be extremely useful for manufacturers looking to assess the design & quality of their devices. With human factors regulations becoming more stringent,5 data about how patients are holding and using devices will be a valuable supplement to human factors studies. Data collected by the device itself can help to prove it is being used as intended and that any risk to patients has been suitably addressed by the device design. Following product launch, this data can also allow companies to track complaints or concerns about the product to establish where any issues may lie. This can be relayed to the device manufacturers enabling them to conduct root cause analysis and make the necessary improvements to the device, or to identify patient groups who need more support or who may even require a device with a different design.
The Future for Connected Drug Delivery Devices
There are still important issues that must be addressed to ensure all parties are able to get the most out of connected drug delivery devices. For pharma companies is paramount to make full use of data around device usage to ensure they bring to market devices that are both cost-effective and user-centric. Meanwhile, at the healthcare level, patient data needs to be better incorporated to allow for improved remote monitoring and personalised treatment plans. With the rapid growth and investment in the connected drug delivery device industry these issues should be solved in the near future to make sure the benefits arising from connected devices are exploited to the fullest.

REFERENCES
1. Biospace. (2022). Injectable Drug Delivery Market Size to Reach USD 83.38 Billion in 2030. https://www.biospace.com/article/
injectable-drug-delivery-market-size-to-reach-usd-83-38-billionin-2030-/?key%C2%ADwords=covid
2. Krummenahcer, F. (2023). Opportunities for innovation with biosimilars. https://ondrugdelivery.com/opportunities-forinnovation-with-biosimilars/

3. US Food & Drug Administration. (2022). Cybersecurity. https:// www.fda.gov/medical-devices/digital-health-center-excellence/ cybersecurity
4. European Commission. Waste from Electrical and Electronic Equipment (WEEE). https://environment.ec.europa.eu/topics/ waste-and-recycling/waste-electrical-and-electronic-equipmentweee_en
5. US Food & Drug Administration. (2016). Human Factors Studies and Related Clinical Study Considerations in Combination Product Design and Development. https://www.fda.gov/ regulatory-information/search-fda-guidance-documents/ human-factors-studies-and-related-clinical-study-considerationscombination-product-design-and
Michael Earl
Michael Earl joined Owen Mumford as Director of Pharmaceutical Services in November 2020. He was previously the Commercial VP at Bespak, leading the commercial team there to drive growth in their substantial medical devices business. Prior to that, he worked for a number of pharma, biotech and device companies. In a career spanning more than 35 years, he has been responsible for all aspects and stages of drug and device development and commercialisation. Michael has also completed a substantial number of commercial, licensing and M&A transactions.
22 INTERNATIONAL BIOPHARMACEUTICAL INDUSTRY Spring 2023 Volume 6 Issue 1 Research / Innovation / Development



www.international-biopharma.com • • • • • •
The Opportunities and Obstacles of Filling and Packaging
Pre-filled Syringes
Pre-filled syringes (PFS) offer plenty of advantages for injectable drug formulations, but also have challenges ranging from sterile integrity requirements to packaging. Robert Fielders, Director, Engineering at Recipharm, presents the benefits that the PFS format gives the pharmaceutical industry and patients and provides advice to solve the common challenges associated with PFS filling and packaging.
The PFS format is increasingly being used for the administration of medicines, with benefits for dose accuracy, ease of use, and reduced patient risk. This is reflected in the rapid growth of the international PFS market, which is expected to be worth $6.5 billion by 2030, up from $3.6 billion in 2021.1
Multiple drivers are contributing to PFS market growth:
Growing Demand for Injectable Biologics and Biosimilars
The biologics market is set to be worth $900 billion by 2030.2 Demand for injectables has grown as a result of the rise in chronic conditions, such as autoimmune diseases or cancers. Biologics are often more selective than conventional medications in targeting the disease-modifying facets of human physiology. Many of these target the immune system, making them prime therapeutics to treat many immune-related chronic diseases. Biologics are often developed for parenteral administration to increase bioavailability as they are often broken down by oral administration. An injectable format that offers patient convenience benefits is highly desirable for treating chronic conditions, and can help therapies stand out in a competitive market.
Planning for Future Pandemics
The global COVID-19 vaccination programme to protect patients from potentially fatal virus symptoms required fast action from the pharmaceutical industry and from governments too. Although the vaccination campaign was highly successful, it flagged areas for improvement. At the time vaccine products needed to be manufactured and delivered efficiently and in high volume using vials to contain multiple doses. A disadvantage to this approach was the patient turnover time at vaccination centres. Each patient required a syringe to be prepared and filled from a vial, adding a cumulative time impact, which restricted the number of vaccinations that could be performed within a day.
There are lessons to be learnt from COVID-19 for future outbreaks or for seasonal flu vaccination programmes. In particular, there needs to be better infrastructure in place to speed up the administration of vaccines to the general public. Learning from the pandemic is crucial and an injectable format that can simplify the vaccine administration process can significantly speed up the turnover of patients, allowing more
people to be vaccinated each day. Ready-prepared injectables, like PFSs, also have the potential to enable self-administered vaccination for tourists against tropical diseases.
Making Injectables Patient-friendly
Traditional injectable therapeutics represent distinct challenges for patients and healthcare professionals (HCPs), which is why PFSs are becoming increasingly attractive to pharma companies.
Possibly the biggest barrier to administration for injectables is that most require direct HCP interaction. HCP-administered injections are a major time burden for patients who have to schedule and travel to a clinic. This may cause patients of working age to lose income as they take time off work, and patients with mobility issues may struggle to travel for their treatment. The process also burdens healthcare systems as HCP resources are occupied while administering injections.
Although self-administration of injectable therapeutics has the potential to ease burdens and enhance adherence, some barriers need to be overcome to see this become a reality. One of the reasons that injectables aren’t as easy to self-administer as other forms of medication is that there are complexities in preparing standard syringes for administration. This can be a large hurdle for patients with dexterity issues, poor eyesight, or many other useability issues that are often associated with age. The negative perception of needles and the practicalities of self-administering injectables in populations with these issues also serve to reduce patient adherence and a reluctance to take on injectable treatments.
This has fuelled a movement from pharmaceutical companies to investigate ways that injectable therapeutics can be made into products that patients are confident to use at home, school, or in the workplace – removing the need for dependence on clinical settings.
The use of a PFS format is viewed as a crucial step in allowing the self-administration of injectable drug products. The simplified preparation and precise drug concentration in every dose enable patients to have peace of mind when self-administering doses. The risk of administering an incorrect dose is minimised by the dosage being pre-determined at the filling stage. This avoids potentially ineffective doses or toxic doses that could be devastating to patient health. Empowering patients to use a PFS to administer their medication provides many advantages – including a significantly enhanced adherence to dosing and the subsequent effectiveness of the treatment. This allows the healthcare system to relieve pressure by taking HCPs away from routine injections.
In short, the ease of use and confidence gained from using a PFS offer benefits for pharmaceutical companies looking to develop more supportive and patient-centric therapeutic approaches not just for vaccines but other applications.
24 INTERNATIONAL BIOPHARMACEUTICAL INDUSTRY Spring 2023 Volume 6 Issue 1 Manufacturing & Processing
PEER REVIEWED
Manufacturing & Processing
The Production Pitfalls of Pre-filled Syringes

Although there are clear benefits to moving injectables to a PFS format, there are also challenges for pharmaceutical companies to implement this. One particular challenge concerns filling and packaging a PFS, where stringent regulatory requirements must be met to produce a successful finished product.
The manufacturing and filling process for a PFS-administered therapeutic is complex in comparison to many other dosage forms. Although there are complexities to developing therapeutics to be administered by PFS, the production challenges are far outweighed by the end benefits of PFS administration. Companies should also be aware of these complexities and know what needs to be considered for a successful PFS production:
Aseptic Processing is Key
Maintaining sterility during all stages of the manufacturing and fill and finish processes is crucial. Any parenteral therapeutic must be sterile when administered, as this route of administration bypasses much of the patient’s immune system and leaves them particularly susceptible to infections. Processing and packaging environments must be aseptic and effectively contained – and a PFS format is no exception to this rule. Aseptic processing is crucial to the safety of patients receiving the therapeutic and compliance is required within the confines of stringent regulations, like the European Union’s (EU) Annex 1.
Adhering to aseptic processing regulations requires production within cleanroom facilities containing restricted access barrier systems (RABs), isolators or other advanced aseptic processing controls. Installation and operation of these facilities are expensive for pharmaceutical companies to manage on their own. It is also difficult to acquire and maintain sterile filling capabilities with a large volume to enable the fulfilment of large-batch projects, like a multinational vaccine rollout.
Another facet of aseptic manufacturing is managing the risk of contamination. The risk of contamination is reduced by introducing environmental controls to prevent the presence of particulate matter in the area and on surfaces, as well as ensuring that the clinical working environment is sanitary. Systematic cleaning regimes with GMP-grade disinfectants are an essential component of maintaining a sterile cleanroom.
Secondary Packaging
The secondary packaging of a PFS presents another issue to manufacturers. The needles are fragile and therefore require careful handling and strong secondary packaging solutions. The contents are packaged into a syringe kit with multiple components, which can complicate the packaging process. In addition to the standard label and plunger rod, a PFS can have a needle, a safety device, which may feature a finger flange or a backstop, alcohol pads for sterilising the skin before an injection, or even information leaflets in the secondary packaging to guide patient users on how to operate the syringe.
INTERNATIONAL BIOPHARMACEUTICAL INDUSTRY 25 www.international-biopharma.com
Manufacturing & Processing
PFS Labelling
Compliant labelling is crucial, particularly when products are being shipped into multiple markets. Each market will require labelling compliance with the relevant local regulations and languages to ensure that patients can understand them and know exactly what they are taking.
PFS Transit
After a PFS has been effectively packaged, it still needs to be transported to where it can be administered. For this, suitable cold-chain supply networks may be required. Many biologics require storage in sub-zero temperatures and shipments may need atmospheric control. The exact temperatures required for the medicine to be effective upon arrival can differ greatly, but for most mRNA vaccines, for instance, the product needs to be stored at -70°C until it is brought to room temperature just before administration. This maintenance of temperature control during storage and shipping is a key component of any parenteral therapeutic journey from factory to bedside, whether the drug is in a PFS or not.
In addition, many major markets, such as the EU, have strict serialisation requirements in place to allow each product within a batch to be tracked from its point of origin all the way to the patient. It is becoming increasingly common for regulatory authorities to trace their PFS and other products as they are transported to patients, to prevent counterfeit products from entering the supply chain.
Meeting the Challenges of PFS Therapeutics
With the growing demand for patient-centric PFS administration combined with the challenges of producing them, many pharmaceutical companies are looking to outsource their PFS manufacture to contract development and manufacturing organisations (CDMOs).

CDMOs that have a strong track record of filling PFS therapeutics and other injectables will be able to offer expertise and support to pharmaceutical companies along the journey to commercialisation. Critically, these CDMOs will already have the necessary dedicated sterile filling infrastructure in place.
The COVID-19 pandemic led some CDMOs to invest in large-volume sterile filling capacity. This was to directly support the production and delivery of billions of vaccine doses into the global pharmaceutical supply chain. The infrastructure and experience gained during the COVID-19 pandemic means these CDMOs are in an optimal position to support pharmaceutical companies in the development of large-batch injectable treatments, including vaccines in PFS format for future pandemics or seasonal boosters.
Looking to the Future
There is plenty of potential in the PFS format and especially when applied to mass treatment campaigns the advantages outweigh the challenges. Enabling flexible and safer administration of injectable therapeutics for chronic diseases and the reduction of HCP burden are reasons why PFS therapeutics are becoming a favoured choice. Because of all this, the market is expected to grow further for the foreseeable future.
Due to the complexities involved in PFS manufacturing, expertise in sterile manufacturing and filling capacity for a PFS-administered therapeutic can ensure an efficient traversal of the challenges involved. Working with expert CDMO partners grants access to facilities and experience that can ensure PFS products are safely and effectively produced for patient use.
REFERENCES
1. https://www.globenewswire.com/news-release/2022/08/18/ 2501065/0/en/Safety-prefilled-Syringe-Market-Size-is-expectedto-reach-at-USD-6-534-Million-by-2030-registering-a-CAGR-of-7-1Owing-to-Increasing-Prevalence-of-Target-Disease-Population.html
2. https://www.precedenceresearch.com/biopharmaceutical-market
Robert Fielder
Robert Fielder has served as the Director of Engineering at Recipharm's specialist aseptic filling and lyophilisation facility at Wasserburg for 17 years. He manages a team of 40 specialists in electrical, mechanical, programming, and media systems, and oversees site maintenance and the acquisition of new machinery and technologies to further improve operations. Robert has led a range of successful site expansion projects and gained extensive experience in the semiconductor, automotive, and electronic industries. His expertise and knowledge continue to drive innovation and success for both Wasserburg and Recipharm.
26 INTERNATIONAL BIOPHARMACEUTICAL INDUSTRY Spring 2023 Volume 6 Issue 1
Our health science experts can support your requests for:
Find out how SGS can help you optimize every aspect of your Health Science operations




Are Nitrosamines a Concern for Biologic Manufacturers?
First described over a century ago, the class of organics known as N-nitrosamines are defined by the common structural feature, R2NNO.
Since the mid-1950s when their carcinogenic nature was revealed,1 this functional class has continued to attract attention by researchers and, today, of the more than 300 nitrosamines identified, 90% are thought to be carcinogenic and/or genotoxi.2
The presence of nitrosamines in a range of foodstuffs and drinks as well as products such as tobacco is well documented. They are known to form during material preparation as well as in the digestive tract itself.3
The greatest risk for the presence or formation of N-nitrosamines comes from the confluence of three factors:
(i) A nitrosating agent
(ii) A secondary or tertiary amine, and
(iii) Appropriate conditions (e.g. elevated temperatures, acidic conditions, liquid phase)4
Presence of Nitrosamines in Medicines
In mid-2018, regulators became aware of the presence of the nitrosamine N-nitrosodimethylamine (NDMA) in certain blood pressure medications.5 Further investigations led to the detection of several N-nitrosamine species in a range of pharmaceuticals including valsartan, antibiotics, antacids and antidiabetics. This resulted in the recall of these drug products and the temporary withdrawal of treatment for many patients globally.
In 2019, SGS adopted a center of excellence strategy for nitrosamine testing, utilizing expertise, sophisticated analytical instruments and method harmonization across its global network to support the pharmaceutical industry.
Beginning in late 2020, several additional products were removed from the market due to the detection of nitrosamine drug substance-related impurities (NDSRIs). 6 These are essentially nitroso forms of the API which result from areaction between a nitrosating agent (e.g. nitrite) and a suitable amine/ amide-containing API under appropriate chemical conditions.7
It is estimated that about 20% of current small-molecule generic drugs have a reactive amine functional group which poses the potential for the formation of NDSRIs. As might be expected however, the genotoxicity of such derivatives can vary significantly depending on the molecular structure of the API.8
Method
Development and Validation by SGS
SGS has already successfully applied its network of specialized
laboratories to tackle the analytical challenges associated with a range of these somewhat unique impurities.
A coordinated regulatory strategy to address potential nitrosamine contamination in existing and new drug products has been established and includes an initial risk assessment followed by appropriate testing and mitigation of the manufacturing processes.9
While much attention was initially focused on traditional pharmaceutical products, in 2020 the EMA published an assessment report10 that directed all medicinal products, including biologics, into the scope of nitrosamine risk assessment. Other regulatory agencies such as Health Canada, Swiss Medic and ANVISA have now also emulated this guidance.
The overall portfolio of services provided by SGS is well equipped to support all aspects of these regulatory strategies, from risk assessment and analytical development to evaluation and routine monitoring.
A Low Level of Nitrosamines in Biologics?
Many biologic products have the potential for nitrosamine contamination from the formation of impurities such as NDMA, NDSRIs or excipient-related nitrosamines. Indeed, given the relative abundance of amine functionalities in biologic products, it may seem that the susceptibility of this therapeutic class to the presence of these genotoxins could be higher than for traditional pharmaceuticals.
However, this would be contrary to the currently held belief that nitrosamine risk factors for biologics are marginal. This position is supported by a number of important considerations including:
(i) Generally, the high-water purity used for the manufacturing, formulation and storage of biologics negates a source of potential nitrosating agents such as nitrates.
(ii) Purification procedures, often based on molecular size, minimize the potential for low molecular mass impurities.
(iii) Biologics are usually processed and stored using conditions that do not favor nitrosamine formation.
(iv) The in vivo generation of potentially mutagenic species from a nitrosated biologic API is considered very unlikely.
(v) Paradoxically, while biologics often do contain multiple reactive sites for nitrosamine formation, their molar abundance and type transforms such products into scavengers – actually reducing the effects from potential nitrosating agents.11 The European Federation of Pharmaceutical Industries and Associations has released a comprehensive review of these factors.12
What is the Risk Level?
Clearly, if the biologics manufacturing process requires use of
28 INTERNATIONAL BIOPHARMACEUTICAL INDUSTRY Spring 2023 Volume 6 Issue 1 Manufacturing & Processing
PEER REVIEWED
a known nitrosating agent, a thorough risk assessment must be performed in the same manner as for any other therapeutic. Generally, however, while the potential for nitrosamine contamination in biologic products is relatively low, for the reasons described above, there are certain risks that have been recognized for this product type:
(i) Today, there are many biologic therapeutics that combine synthetically derived elements with those from cellular biosynthesis.
Indeed, there are now examples of complex peptides and proteins, produced entirely through synthetic processes; erythropoietin is one such example.13
In these circumstances, when performing a risk assessment, the chemically produced components and intermediates should be considered as having the same potential for nitrosamine impurities as pharmaceutical products, although this is often mitigated by various methods of purification.
(ii) Container closure systems incorporating components such as elastomeric vial stoppers are a well-documented potential source of nitrosamines.14
Recently, reaction between nitrocellulose and an aminecontaining printing primer (components of blister primary packaging material) has been found to create nitrosamines15 which, under certain conditions, can transfer into the final product.
(iii) While many of the most commonly used excipients such as
inorganic salts, sugars, polyols and surfactants are of very little concern in terms of nitrosamine impurities, others, such as the antioxidant polyethylenimine may actually inhibit nitrosamine formation.16 Stabilizing agents such as proline, arginine and glutamate are certainly capable of reaction with nitrosating agents, but the products from most amino acids are not carcinogenic.17
Nevertheless, similar to nitrites, the potential risk from the presence of a reactive amine present in trace amounts in any excipient type will depend on the formulation composition and should be appropriately evaluated.
Ongoing Challenges Posed by Nitrosamines in Biologic Products
Clearly, there can be no single approach to solving the nitrosamine challenge and, even for the same product, a variety of solutions may be considered appropriate. For existing products, a thorough risk assessment is essential to provide confidence in the manufacturing, transport, and storage processes and the quality of raw materials.
For new products, such a risk assessment provides a means of minimizing the potential for nitrosamine contamination by revising the manufacturing processes or even proactively making use of nitrosating inhibitors or scavengers such as propyl gallate, ascorbic acid or maltol.18
If analytical evaluation is necessary, biologic products may pose some unique challenges. Investigation of possible contamination by nitrosamines such as NDMA may be complicated because of

INTERNATIONAL BIOPHARMACEUTICAL INDUSTRY 29 www.international-biopharma.com Manufacturing & Processing
Manufacturing & Processing
interference from excipients such as surfactants, commonly used for biologic product formulations.

In contrast to the majority of pharmaceutical products, biologics usually contain numerous sites for nitrosation, thereby potentially giving rise to multiple NDSRI products – a difficult position to investigate and define. However, the expertise and capabilities of SGS’s biologics and nitrosamine teams mean they can provide highly effective solutions to these complex analytical challenges.
The assertion that biologic products are at low risk of nitrosamine or NDSRI contamination seems well founded, and to date there have been no market withdrawals for this product class due to nitrosamine-related issues.
However, the significant diversity in molecular type, manufacturing processes and supply chains used for biologic therapeutics create new potential routes for nitrosation. It is therefore critical that the industry maintains its vigilance vis-à-vis these harmful impurities.
REFERENCES
1. Magee, P.N.; Barnes, J.M. The production of malignant primary hepatic tumours in the rat by feeding dimethylnitrosamine. Br. J. Cancer 1956, 10, 114–122.
2. Byran, N.S. and Grinsven, H.v, Advances in Agronomy. Academic Press. 2013-01-08. p. 159. ISBN 978-0-12-407798-0.
3. C. Lintas, A. Clark, J. Fox, S.R. Tannenbaum, P.M. Newberne, In vivo stability of nitrite and nitrosamine formation in the dog stomach: effect of nitrite and amine concentration and of ascorbic
acid, Carcinogenesis, Volume 3, Issue 2, 1982, Pages 161–165.
4. The International Pharmaceutical Excipients Council Position Paper (2022): The Role of Excipients in Determining N-Nitrosamine Risks for Drug Products: (https://www.ipec-europe.org/ uploads/publications/202203-if-nitrosamines-position-paperfinal-1646123452.pdf).
5. European Medicines Agency. EMA reviewing medicines containing valsartan from Zhejiang Huahai following detection of an impurity, 2018, ( www.ema.europa.eu/news/ema-reviewingmedicines-containing-valsartan-zhejiang-huahai-followingdetection-impurity).
6. https://www.fda.gov/safety/ recalls-market-withdrawals-safety-alerts/pfizer-expands-voluntarynationwide-recall-include-all-lots-chantixr-varenicline-tablets-due to N-N-Nitroso Varenicline Content (2020).
7. Joerg Schlingemann, Michael J. Burns, David J. Ponting, Carolina Martins Avila, Naiffer E. Romero, Mrunal A. Jaywant, Graham F. Smith, Ian W. Ashwort, Stephanie Simon, Christoph Saal, Andrzej Wilk, The Landscape of Potential Small and Drug Substance Related Nitrosamines in Pharmaceuticals, J. Pharm. Sci., 2022.
8. Giovanni Brambilla and Antonietta Martelli, Genotoxic and carcinogenic risk to humans of drug–nitrite interaction products, Mutation Research/Reviews in Mutation Research Volume 635, Issue 1, January–February 2007, Pages 17-52.
9. Control of Nitrosamine Impurities in Human Drugs, Guidance for Industry, USFDA (2021),(https://www.fda.gov/media/141720/ download).
10. Nitrosamine impurities in human medicinal products, June 2020 EMA/369136/2020 Committee for Medicinal Products for Human Use (CHMP), Procedure under Article 5(3) of Regulation EC (No) 726/2004.
11. Kato, T. and Kikugawa, K. (1992) Proteins and amino acids as scavengers of nitrite: inhibitory effect on the formation of nitrosodimethylamine and diazoquinone. Food and Chem Tox, 30(7), 617-626.
30 INTERNATIONAL BIOPHARMACEUTICAL INDUSTRY Spring 2023 Volume 6 Issue 1
Manufacturing & Processing
12. European Federation of Pharmaceutical Industries and Associations, (2020), N-nitrosamine Impurities in Biological Medicinal Products (https://www.efpia.eu/media/580595/n-nitrosamine-impuritiesin-biological-medicinal-products.pdf).
13. Ping Wang, Suwei Dong, Jae-Hung Shieh, Elizabeth Peguero, Ronald Hendrickson, Malcolm A. S. Moore, and Samuel J. Danishefsky (2013), Erythropoietin Derived by Chemical Synthesis, Science.3; 342(6164): 1357–1360.
14. Bettine Boltres, (2021), Evaluating Nitrosamines from Elastomers in Pharmaceutical Primary Packaging, PDA Journal of Pharmaceutical Science and Technology, 012645.


15. Nejc Golob, Rok Grahek, Malcolm Ross , Robert Roškar (2022), Nitrocellulose blister material as a source of N-nitrosamine contamination of pharmaceutical drug products, Int J Pharm, 25;618:121687
16. Jianfeng Lou, Thomas S. Buszta, and Michael D. Gernon, (2002) NITROSAMINE-INHIBITING COMPOSITIONS FOR SHORTSTOPPING OF FREE RADICAL EMULSION POLYMERIZATIONS, Patent No.: US 6,495,065 B1.

17. Garcia, H. and Lijinsky, W. (1973) Studies of the tumorigenic effect in feeding of nitrosamino acids and of low doses of amines and nitrite to rats. Zeitschrift fur Krebsforschung und Klinische Onkologie; 79, 141-144.
18. Miha Homšak, Marko Trampuž, Klemen Naveršnik, Zoran Kitanovski, Mateja Žnidarič, Markus Kiefer and Zdenko Časar, (2022), Assessment of a Diverse Array of Nitrite Scavengers in Solution and Solid State: A Study of Inhibitory Effect on the Formation of Alkyl-Aryl and Dialkyl N-Nitrosamine Derivatives, Processes, 10(11), 2428.
Mark Rogers
Mark received his PhD in Biochemistry from the University of Westminster, London. After a post-doc position in the Biochemistry department of Imperial College, London, he spent three years as a lecturer in the Endocrinology department at St Mary's Hospital conducting research into diabetes. He then joined M-Scan in the UK and a year later transferred to M-Scan Inc where he held the position of Vice-President from 1991 to 2010. After acquisition of the company by SGS in 2010, Dr. Rogers remained as the General Manager until 2014 when he became the Senior Vice President for the North American Life Sciences division of SGS.
INTERNATIONAL BIOPHARMACEUTICAL INDUSTRY 31 www.international-biopharma.com
Application Note
Analytical Method Release and Stability Platform for RNA Drug Substance
As a leader in cell and gene therapy (CGT) manufacturing and testing for 25 years, Aldevron has built superior analytical capabilities and expertise to support characterisation, release, and stability testing of internally manufactured products. Aldevron has evolved with this growing industry and expanding regulatory landscape. In addition to this internal knowledge growth, Aldevron has made strategic hires to further enhance its analytical knowledge base. Aldevron uses a life cycle approach to analytical method development and validation as outlined in several recent guidance documents, including USP <1220> , ICH Q2 , and ICH Q14.
Offering analytical testing at the same site as manufacturing provides a key strategic asset supporting the contract development and manufacturing organization (CDMO), helping fill an extensive and growing analytical testing shortage in the CGT industry. Our integrated manufacturing and testing services provide quality and speed – robust and unique advantages for our clients.
Aldevron offers comprehensive analytical support in the Research & Development space to aid the development of commercial products. This end-to-end support includes:
• Method development
• Method validation and transfer
• Process characterisation testing
• In-process testing
• Process validation testing
• GMP release testing in a QC (Quality Control) environment
Aldevron’s Quality Control laboratory offers a high level of compliance. As a fully GMP laboratory, clients can be assured that testing is performed under the highest level of good documentation practices, analyst training, instrument qualification and software validation. ALCOA+ principles are applied across the analytical space, especially for method validations, stability, and release testing. Data integrity is assured through document control, archiving, and audit trail review.
With Aldevron now part of the Danaher group of companies, the opportunities to optimise and advance our analytical capabilities are enhanced through close working relationships with industry leaders such as Precision NanoSystems Inc. (PNI), IDT, SCIEX, Molecular Devices, and Beckman Coulter. These collaborative relationships further expand Aldevron’s expertise and scope of services and technologies that includes next generation plasmids, such as Nanoplasmids and RNA backbones, process development and manufacturing, and in vitro transcription and gene editing enzymes for gene and cell therapies. This unity under one roof provides solutions
and support for our customers to meet their specific needs. Putting the client first, Aldevron is positioned to assist through the full process of end-to-end manufacturing that improves the customer journey from the clinical trial phase all the way through to commercialisation.
Analytical Characterisation for Drug Substance
The mRNA drug substance process utilises enzymatic reactions that include different 5'-cap structures (i.e., Cap0 vs Cap1), variable 3'-poly(A) tail length, and truncated mRNA transcripts. This can produce a mixture of product variants and other notable impurities that include double-stranded RNA (dsRNA) molecules and residual plasmid DNA templates. Despite purification steps to remove these unwanted byproducts, the risk of carrying a small portion of impurities remains. Therefore, such product quality attributes should be characterised during in-process and lot release testing of the purified mRNA.
Aldevron Recommended Drug Substance Release Methods
The analytical method validation team at Aldevron is co-located with the Quality Control laboratory, which optimises speed from development through release. Quality attributes expected for release of biologicals are outlined in Q6B Specifications. The general recommendation is to test for Appearance, General Tests, Content/Quantity, Identity, Purity/ Impurities, and Potency/Activity to cover all quality attributes. The recommended panel outlined in Table 1 (below) includes at least one of each of the recommended quality attributes, with the exception of potency/activity. This panel also covers assay types recommended in the USP draft guidance, “Analytical Procedures for mRNA Vaccine Quality,” to create a comprehensive testing strategy for mRNA products.
Methods shown in Tables 1 and 2 are currently available and have been validated using a matrix approach following Quality by Design (QbD) principles. This means that if a client product is within the defined design space, little or no sample qualification is needed. This offers speed and affordability, especially for early-stage projects. For example, the concentration method has been validated for a range of RNA sizes (2 kb to 17 kb), formulations (TE, Tris, Water for Injection, and citrate) and concentrations (0.5 to 4.0 mg/mL). This comprehensive testing panel will ensure a high-quality product with high confidence for regulatory filing approval. Using the recommended platform provides shorter turnaround times for qualifications of new products.
Stability-indicating Methods
Certain methods can be considered stability-indicating based on historic knowledge and characteristics demonstrated during method development. Monitoring product stability is a regulatory expectation and is needed to assign the shelf life. Table 1 indicates methods that are suitable for stability. In general, purity/integrity methods are the best methods
32 INTERNATIONAL BIOPHARMACEUTICAL INDUSTRY Spring 2023 Volume 6 Issue 1
for monitoring the stability of the product over time. Purity/ integrity methods measure intact products and, as the product degrades, the relative percentage of the intact product will decrease and degradation products will increase. Productrelated impurities such as degradants and multimers are also appropriate indictors of stability and are often reported using the same method as those used for purity. Either intact product (purity/integrity), degradation products (impurity), or both can be reported out by the assay and trended over time. As products degrade, the sample colour or clarity could be altered and appearance can change. RNA concentration by SoloVPE will be included in the stability panel. While not a true stability indicating method, since degraded product will still absorb UV, concentration is included in stability studies to provide a baseline value over time.
Identity is not a stability-indicating method. Once the identity of the material placed on stability is confirmed, the
identity will not change over time. Residual process-related impurities should not be considered for stability studies. Examples include residual plasmid DNA, residual protein, and residual dsRNA. These are parts of the manufacturing process that are cleared by the purification process down to exceptionally low levels. Once release testing confirms that these have been sufficiently removed, there is no future opportunity for them to be introduced into the product over time. Similar rationale applies to not including contaminant testing on the release panel.
5’ Cap and 3’ poly(A) Tail Methods
The 5’ Cap and 3’ Tail methods have been qualified as platform methods, however each new product will require some level of development activity to assess sequence-specific and matrix variation. Given the complexity of the 5’ Cap and 3’ poly(A) tail methods, longer lead times are needed for these product-specific qualifications, which require some custom
INTERNATIONAL BIOPHARMACEUTICAL INDUSTRY 33 www.international-biopharma.com INTERNATIONAL BIOPHARMACEUTICAL INDUSTRY 33 Application Note
Attribute Method Assay Category Stability-Indicating Visual Appearance Clarity and Color (Ph.Eur. 2.2.1 and Ph.Eur. 2.2.2) General Test (Compendial) Y pH pH (USP<791>, Ph.Eur. 2.2.3) General Test (Compendial) Y Concentration UV spectrophotometry by SoloVPE Quantity/Content Y Identity RT-Sanger Sequencing Identity N Identity Capillary electrophoresis (Fragment Analyzer) Identity (Separation occurs though a gel matrix and Identity is confirmed relative to size markers) N Purity/Integrity Capillary electrophoresis (Fragment Analyzer) Purity/Integrity (Separation occurs though a gel matrix and purity are calculated as % intact/% total) Y Residual pDNA Process-related impurity qPCR Process-related impurity (Amplification occurs using product-specific primers and probe) N dsRNA Processrelated impurity ELISA Process-related impurity (ELISA-based method using antibody (J2) specific to dsRNA) N Residual Impurity –Protein NanoOrangeTM Process-related impurity (NanoOrange reagent binds to protein. Relative levels quantitated by fluorescence detection) N Endotoxin Kinetic Chromogenic LAL Process-related impurity N Bioburden Membrane filtration or pour plate (USP<61>,PhEur2.6.12) Safety (Compendial) (Recommended for non-sterile products) N
Table 1. Recommended Core Assay Panel for mRNA Current release and stability panel for RNA testing methods recommended by Aldevron to ensure quality and compliance.
Table 2 provides a summary of the 5’Cap and 3’ poly(A) methods. Table 2. 5’ Cap and 3’ polyA Tail methods
development work for each new construct. To reduce cycle times, these methods can be considered as characterization methods for engineering and early phase GMP lots. These can be performed as release methods as the product moves forward in the life cycle. Note that even when testing is performed as characterisation, the results will be suitable for inclusion in a regulatory filing, as good documentation and traceability will be utilised.
Most poly(A) tails are encoded, and the size of the poly(A) tails is uniform. Therefore, Aldevron has a method available that focuses primarily on confirmation of the relative length of the poly(A) tail by comparison to synthetic poly(A) fragments of known length. The assessment of relative tail length can be useful for assessment of stability. Reporting as percent tailed can also be accommodated with the current procedure.
Experience and Capabilities in Action
Client-specific Methods
While Aldevron offers a comprehensive testing panel for RNA, we understand that certain client products may have unique features or activities that require more specialised analyses. In cases where the client needs a custom assay, Aldevron has considerable breadth of expertise internally to accommodate a wide variety of method types. Client-specific methods can either be developed internally based on client needs or transferred in from the client. Aldevron’s internal procedures for assay transfers are aligned with regulatory expectations, particularly USP General Chapter <1224> “Transfer of Analytical Procedures.”
Aldevron provides analytical support for many clients in multiple therapeutic areas at various stages of clinical development. This experience has provided Aldevron with a solid background in setting phase-appropriate specifications to ensure quality and compliance, as directed by regulatory authorities. Specifications can be set more widely for early phase projects, relying heavily on prior knowledge and functional requirements. Aldevron’s extensive experience allows for setting meaningful, phase-appropriate specifications that ensure product quality while allowing flexibility for the innovation that regulatory authorities expect for new products. As product testing and manufacturing knowledge expands, the specifications will be appropriately updated. Justification of specifications is documented so that it is available for filing support.
Regulatory Support
We are not only focused on meeting the unprecedented market demand, where testing queues are at all-time highs, but we also are at the forefront of the requirements for regulatory authorities. This enhances speed to market by expediting the path to approval, by providing customers with advanced analytical methods and platform assays to demonstrate potency, purity, identity, and safety. Since Aldevron’s platform methods are developed, validated, and documented in a systematic, compliant manner, relevant analytical information is easily converted to filing-ready content in CTD (Common Technical Document) format. Therefore, support for authoring analytical sections 3.2.S.4 is efficient and seamless. These efforts are supported by analytical subject matter experts as well as an internal regulatory affairs team.
Capacity
The mRNA manufacturing process is extremely sensitive to degradation and should be separated from other cell-based processes. To eliminate any risk, a dedicated manufacturing environment for mRNA is necessary to proceed to the next stage of drug manufacturing. Furthermore, if there is a need to produce multiple mRNA products in the same manufacturing line, the risk of crossover and contamination is amplified and needs to be mitigated. Aldevron has expanded its campus in area, with multiple sites using state-of-the-art modular cleanrooms with integrated building management systems and environmental monitoring for cell banking, inoculation, and fill/finish. This capacity allows the production of clinical and commercial products in GMP quality grades for multiple clients with the highest quality and purity for drug products.
Strategic Partnership
Under the Danaher Operating Company umbrella, Aldevron works closely with PNI, IDT, SCIEX, Molecular Devices, and Beckman Coulter to enhance mRNA manufacturing and analytical capabilities and streamline the end-to-end workflow for their clients. The collection of technologies and expertise helps streamline the process for manufacturing, meeting regulatory compliance, and CMC (Chemistry, Manufacturing, and Control) filing. With insight gained through this collaboration, the focus is on improving and innovating new methods and technologies needed to provide high-quality products to customers.
Conclusion
Aldevron has embraced the life cycle approach and is well-
34 INTERNATIONAL BIOPHARMACEUTICAL INDUSTRY Spring 2023 Volume 6 Issue 1 Application Note
Specifications
Attribute Method Example
Assay Category Stability-Indicating Purity-Cap integrity
–Identification of enzymatic fragments % Capped Purity/Integrity Y Purity/IntegrityPoly(A) efficiency
–Identification of enzymatic fragments % Polyadenylated and/or Relative poly(A) tail length Purity/Integrity Y
Acceptance Criteria
5' Cap IP-RP-HPLC
3' Poly A Tail (RP-HPLC)
Application Note
positioned to maintain a leadership role in the industry. Our internal procedures are already in compliance with the recently effective USP<1220> and the recent draft guidance ICH Q14. As part of the life cycle approach to analytical methods, the assay panel is optimised throughout all phases including continuous improvement. Therefore, Aldevron is well-positioned to support release and stability testing for mRNA drug substance to meet customer specific requirements. With strong commitment to assay life cycle management, we are also dedicated to continuously improving methods and adding innovative technologies. Therefore, strategic partnership expedites products to market with advanced support to demonstrate potency, purity, identity, and safety.


Aldevron
Aldevron is a premier manufacturing partner, producing high-quality plasmid DNA, proteins, enzymes, and other key components for the development of vaccines, gene and cell therapies, immunotherapies, veterinary medicines, agricultural biotechnology, and molecular diagnostics. Headquartered in Fargo, North Dakota, Aldevron supports scientists who are developing revolutionary, lifesaving treatments for millions of people. To learn more about how Aldevron is advancing biological science, visit www.aldevron.com;
Experience Counts
From concept to commercial supply, industry leaders rely on Aldevron
An experienced CDMO can help you avoid potential rework and support your project from early phase research, through clinical trials, and commercialization. Since 1998, it has been Aldevron’s mission to help our clients make meaningful contributions to patients’ lives. Here are just a few of the ways we support your objectives:
• pDNA, RNA & protein custom manufacturing
• Scale for commercial applications
• Research-grade & cGMP material
• Standardized, in-stock products
• Process development
• Technology transfer
• Analy tical methods & assays
• Regulatory support
INTERNATIONAL BIOPHARMACEUTICAL INDUSTRY 35 www.international-biopharma.com
Contact us today to get started. 4055 41st Avenue South, Fargo, ND 58104 USA +1 (701) 297-9256 Toll-free (U.S. and Canada): +1 (877) 787-3362 a ldevron.com
Beyond Symptom Relief: Human iPSC-derived Models for the Development of Life-changing Therapies for Neurodegenerative Diseases

The complexity and epidemiology of neurodegenerative diseases demands the incorporation of alternative approaches for the development of disease-modifying therapies that can bring real improvements to patients. iPSC-derived models are based on human biology offering unique characteristics which are greatly benefiting early and preclinical drug development. In this editorial we discuss the status of drug discovery and development for Alzheimer’s disease (AD), Parkinson’s disease (PD) and Amyotrophic Lateral Sclerosis (ALS), focusing on promising candidates identified with the help of iPSC technology.
Background
Neurodegenerative diseases (NDDs) are a heterogeneous group of diseases characterised by progressive neuronal cell death that leads to gradual loss of motor, sensory and/or cognitive functions. Most available treatments for NDDs only attempt to alleviate symptoms or slow disease progression, rather than the root cause of the disease. Meanwhile the incidence of these diseases is rising dramatically due to increased life expectancy and aging population, creating an urgent need for disease-modifying therapies.1
The FDA estimates that for every new drug approved for NDDs, approximately 40 have failed in clinical trials, of which many were initially seen as highly promising2 in preclinical settings. One of the main reasons for this high risk of failure is the “translational gap”: drugs that work during preclinical testing often fail to show efficacy or present safety issues in clinical trials.3 Interspecies differences between animal models typically used for preclinical testing and humans, greatly contribute to this translational gap. In addition, sparse understanding of the genetic and mechanistic basis of neurodegenerative diseases hampers the identification of key targets with the capacity to really modify the disease. Although there have been significant advancements in this area, the complexity of the brain and the lack of access to neuronal human tissue has hindered further progress.3
Under these circumstances, there seems to be a clear need to explore alternative approaches to better facilitate target identification and advance therapeutics with higher confidence throughout the pipeline.
The Value of Human iPSCs in Drug Discovery
In early drug discovery models relying on immortalised cells are commonly used, as they are relatively simple to culture, amenable to scale up for high-throughput screening and present a relatively low cost. These models have helped advance drug discovery for decades but have repeatedly shown to have limited physiological relevance and reproducibility. Primary human cells and tissues offer an alternative to address those challenges, as they are physiologically relevant and can help
understand disease pathology and the impact of potential therapeutic candidates. Unfortunately, lack of access to those materials, especially neuronal cells, as well as difficulty keeping them in culture for useful periods of time prevent primary cells from being a viable option for high-throughput applications.3 Preclinical testing is usually performed on animal models. Using complex organisms allow for the assessment of behaviour, cognition, and physiology providing valuable information about disease mechanisms as well as drug safety. Nonetheless, interspecies differences may explain most of the withdrawals in clinical stages. To illustrate, most mouse models do not develop key neuropathological phenotypes such us neurodegeneration or neuroinflammation.4 In many cases, key proteins and pathways involved in the onset of NDDs are not conserved in rodents5 and the massive overexpression of genes needed to induce a mild symptomatology do not relate to human disease. Moreover, there are substantial differences in metabolism, which directly impacts drug responses.6 Other limitations are expected because of their less-developed brain and shorter lifespan which hampers the study of age-related diseases.4
Human induced pluripotent stem cells (iPSCs) are obtained from donors and reprogrammed to their pluripotent stages. This provides an unlimited source of human cells7 that can be efficiently differentiated into the major types of neurons and glial cells, affording access to relevant cells without the challenges of primary cells. iPSC-derived models are physiologically relevant and can recapitulate diseaseassociated phenotypes in vitro, as iPSC technology preserves the donor’s genetic background, allowing developers to model both familial (monogenic) and sporadic NDDs (multi-factorial).8 In addition, comparisons between patient-derived and healthy iPSC models enable the detection of physiological deviations at the cellular level and facilitate the identification and validation of key targets within a physiologically relevant context.
Overall, the incorporation of iPSC-derived models into therapeutic development for neurodegenerative diseases can increase the confidence on drug-response predictions and facilitate more confident decision-making by defining relevant go/no-go criteria earlier in the development and screening process (Figure 1).
36 INTERNATIONAL BIOPHARMACEUTICAL INDUSTRY Spring 2023 Volume 6 Issue 1 Therapeutics
PEER REVIEWED

Alzheimer’s Disease
Alzheimer’s disease (AD) is a type of dementia that progressively deteriorates memory, thinking and behaviour. It’s the most common NDD, affecting more than 36 million people in the world.9 Main hallmarks of AD are the formation of amyloid-β (Aβ) plaques and the aggregation of pathologic Tau that eventually lead to neuronal cell death in the cortex and hippocampus.3 Most cases of AD are sporadic, but several gene mutations have also been associated with familial cases of AD.3
Despite the vast number of therapies under development, all currently approved treatments improve cognitive and behavioural symptoms without altering the course of the disease. It has been reported that 99% of clinical trials fail to show any treatment efficacy.10 Even the only exception reaching the market in 2020, Aducanumab, is facing fierce controversy about its efficacy, leading to market withdrawals.11 However, efforts remain: there are currently 143 unique therapies for AD being investigated in clinical trials, 85% of which are disease-modifying therapies.12 To increase the chances of success, researchers are now investigating the role of non-neuronal cells in AD pathology and looking for alternative models to diversify the number of targets available.
Human iPSC-derived neurons from AD patients recapitulate the key pathological hallmarks of AD 13,14 and can be co-cultured with iPSC-derived astrocytes or microglia to generate a more relevant environment 14,15 To illustrate, a phenotypic screening of 1684 approved and preclinical drugs identified 96 compounds that were able to inhibit Tau accumulation in iPSC-derived neurons from AD patients.16 In line with previous findings,17 cholesterol metabolism was found to be an upstream regulator of Tau in the early stages of AD and a new potential target for drug discovery. In the same study, an efficacy and toxicity screening was performed with iPSC-derived neurons and astrocytes, which identified a new druggable pathway to modulate cholesterol metabolism and Tau accumulation without affecting astrocyte homeostasis.16
Additionally, iPSC technology can improve patient stratification for clinical trials. A drug-repurposing screening with 1258 compounds was performed on cortical neurons derived from AD iPSCs and showed three drugs that were effective in reducing Aβ plaques.18 Before moving into clinical trials, iPSC technology was used to confirm the efficacy and
select the most optimal population for the study. Among the 3 drugs, bromocriptine showed the strongest Aβ-reducing effect, being more effective for people with a particular form of familial AD.19
Parkinson’s Disease
Parkinson’s disease (PD) is the second most common NDD, affecting more than 10 million people worldwide.1 It causes unintended movements, stiffness and difficulty with balance and coordination. PD is characterised by abnormal aggregation and accumulation of α-synuclein protein that leads to the progressive loss of dopaminergic neurons in the substantia nigra.20 Most PD cases are sporadic, but ~7% of patients have monogenic forms of the disease.3
Available treatment options are mainly dopamine repleting, which was discovered 55 years ago and increases quality of life and life expectancy.21 It wasn’t until 2020 that the first non-dopaminergic medication, istradefylline, was approved by the FDA. This drug improves motor outcomes and increases the duration of time without tremor.22 However, none of these therapeutics reverse PD progression, indicating the need to identify new targets that can really change the course of the disease.
Human iPSC-derived models that faithfully recapitulate the disease phenotype can be of great advantage to improve target identification. As an example, in a study with an iPSC-derived model of PD, 1165 FDA-approved compounds were evaluated to rescue mitochondrial toxicity and neuronal cell death phenotypes. Examination of hit compounds revealed benidipine, a T-type calcium channel inhibitor, as a new effective lead candidate.23 An independent study found flunarizine, another T-type calcium inhibitor, as a suppressor of mitophagy abnormalities in a similar iPSC-based model of PD.24 Altogether, iPSC technology helped identify two lead candidates and the regulation of intracellular calcium levels as a new therapeutic target to suppress PD progression.
Furthermore, iPSC-dopaminergic neurons derived from patients with monogenic forms of PD have helped identify new disease-associated phenotypes, such as compromised neurite outgrowth, reduced neurite complexity or axonal degeneration.25 These morphological alterations were used to evaluate the efficacy of compounds in rescuing those pathological features. Interestingly, an α-synuclein-inhibiting

38 INTERNATIONAL BIOPHARMACEUTICAL INDUSTRY Spring 2023 Volume 6 Issue 1 Therapeutics
Figure 1. The incorporation of iPSC-derived models into drug discovery for neurodegenerative diseases is an approach that brings multiple benefits to accelerate the development of disease-modifying therapies.





Your Degassing Expert www.biotechfluidics.com Europe: Biotech AB Phone: +46 300 569 180 info@biotechfluidics.com United States: Biotech USA LLC Phone: 612 703 5718 sales@biotechfluidics.com Japan: BioNik Inc. Phone: +81 545 389 125 info@bionikinc.com BIOTECH REFRACTiMASTER® A new Refractive Index Detector — Truly Built for Modern HPLC Analysis
Therapeutics
compound that has reached Phase II clinical trials successfully restored neurite length and rescued axonal pathology during preclinical testing.26
Therapeutic developers are now focusing on the development of gene therapies to lower the expression of genes associated with PD onset, such as SNCA. iPSC technology is also a relevant testing platform for these therapies. In fact, a study has already shown effective reduction of a-synuclein levels in patient-derived dopaminergic neurons after exposure to a SNCA-specific antisense oligonucleotide. 27 These observations will help in the development of new therapies for patients with sporadic or familial PD.
Amyotrophic Lateral Sclerosis (ALS)
Amyotrophic lateral sclerosis (ALS) is a rare neurological disease affecting more than 500.000 people worldwide, with an average life expectancy of about 2-5 years from the time of diagnosis.1 ALS is characterised by muscle atrophy and respiratory failure. A key pathological hallmark of ALS is the accumulation of proteins, such as TAR DNA-binding protein 43, or fused in sarcoma (FUS) that leads to the loss of motor neurons. Most ALS cases are sporadic (~90%), and genetic studies have linked more than 30 genes to familial cases.3
The first medication approved for ALS patients was rilutek, in 1995, which prolongs survival but does not reverse nerve damage. In 2017, after more than 13 years of development, edaravone was approved. It reduces oxidative stress and may attenuate motor neuron degeneration, but it seems to be only effective on a well-defined group of patients with early ALS.28
Given the lack of understanding of the onset of ALS for most patients, patient-specific iPSC-derived motor neurons offer the opportunity to bring patient’s genome and phenotypes into a dish to identify lead therapeutic candidates with agnostic screenings. As an example, retigabine, an FDA-approved potassium channel inhibitor, effectively blocked the pathological hyperexcitability and improved neuron survival in iPSC-derived motor neurons from ALS patients.29 Based on the relevance of this phenotype in ALS pathology and the absence of relevant animal models, retigabine was directly moved into a phase II clinical trial.30 In another drug-repositioning study, three lead candidates were identified for their ability to rescue neurite retractions, hyperexcitability and autophagy levels in iPSC-derived motor neurons from ALS patients.31 The three candidates are currently being investigated in clinical trials.31 One of these 3 compounds, ropinirole, was screened on 32 patient-derived motor neurons, being able to discriminate specific patient responses to the drug32 and it is now being manufactured to be commercialise in Japan.
Phenotypic screens with iPSC-derived neurons from ALS patients also offer the possibility to validate known and discover novel targets with high confidence. A study with a multistep screening of 2899 compounds identified 13 targets that modulate motor neuron excitability and found a new class of candidate drugs, agonists to the dopamine D2 receptor, with the ability to reduce hyperexcitability.33
Facilitating iPSC-solutions
Most reported iPSC-based screens for neurodegenerative
diseases assess approved or experimental drugs rather than large compound libraries. This is partially due to the significant expertise and time required to effectively differentiate iPSCs and develop optimal assays with these models. Partnering with expert organisations like Ncardia, facilitates the differentiation and assay development to make iPSC-derived models available for high-throughput screenings in the early stages of therapeutic development (Figure 2).
With more than 10 years of iPSC experience, the scientific team at Ncardia has the required expertise to generate iPSC-derived neuronal cells, astrocytes and microglia in a time-effective and reproducible manner. These iPSC-derived cell types have successfully been used to develop processes for modelling processes for disease modelling, which can be fully customised according to customers’ needs.14,34 Ncardia’s large-scale manufacturing capabilities enable batch-to-batch reproducibility and allow for high-throughput screening of large libraries.35 Moreover, Ncardia is equipped with in-house readout systems to develop physiologically relevant assays for a wide range of neurodegeneration-associated phenotypes.36 Selection of optimal assay conditions and appropriate readouts is ensured for each project to enable screening of any modality, whether it is a small molecule, RNA therapeutic, monoclonal antibody or gene therapy.
Overall, Ncardia combines deep iPSC knowledge, broad assay capabilities and a demonstrated ability to integrate the biology of human diseases into preclinical research to help therapeutic developers make critical decisions earlier and with higher confidence.

40 INTERNATIONAL BIOPHARMACEUTICAL INDUSTRY Spring 2023 Volume 6 Issue 1
Figure 2. Ncardia’s human iPSC-based solutions ensure a smooth transition from each step in drug discovery while delivering clinically relevant outcomes in a time-efficient manner
REFERENCES
1. Han C, Chaineau M, Chen CXQ, Beitel LK, Durcan TM. Open science meets stem cells: A new drug discovery approach for neurodegenerative disorders. Front Neurosci. 2018;12(FEB):47. doi:10.3389/FNINS.2018.00047/BIBTEX
2. The Path Forward: Advancing Treatments and Cures for Neurodegenerative Diseases – 07/29/2021 | FDA. Accessed July 5, 2022. https://www.fda.gov/news-events/congressional-testimony/ path-forward-advancing-treatments-and-cures-neurodegenerativediseases-07292021
3. Pasteuning-Vuhman S, de Jongh R, Timmers A, Pasterkamp RJ. Towards Advanced iPSC-based Drug Development for Neurodegenerative Disease. Trends Mol Med. 2021;27(3):263-279. doi:10.1016/J.MOLMED.2020.09.013
4. Vitek MP, Araujo JA, Fossel M, et al. Translational animal models for Alzheimer’s disease: An Alzheimer’s Association Business Consortium Think Tank. Alzheimer’s Dement Transl Res Clin Interv. 2020;6(1). doi:10.1002/TRC2.12114
5. Krus KL, Strickland A, Bloom AJ, et al. Loss of Stathmin-2, a hallmark of TDP-43-associated ALS, causes motor neuropathy. Published online 2022. doi:10.1016/j.celrep.2022.111001

6. Potashkin JA, Blume SR, Runkle NK. Limitations of Animal Models of Parkinson’s Disease. Parkinsons Dis. 2011;2011.
Therapeutics
doi:10.4061/2011/658083
7. Takahashi K, Tanabe K, Ohnuki M, et al. Induction of pluripotent stem cells from adult human fibroblasts by defined factors. Cell. 2007;131(5):861-872. doi:10.1016/J.CELL.2007.11.019
8. Valadez-Barba V, Cota-Coronado A, Hernández-Pérez OR, et al. iPSC for modeling neurodegenerative disorders. Regen Ther. 2020;15:332. doi:10.1016/J.RETH.2020.11.006
9. Dementia. Accessed August 8, 2022. https://www.who.int/ news-room/fact-sheets/detail/dementia
10. Cummings J, Feldman HH, Scheltens P. The “rights” of precision drug development for Alzheimer’s disease. Alzheimer’s Res Ther 2019 111. 2019;11(1):1-14. doi:10.1186/S13195-019-0529-5
11. van Bokhoven P, de Wilde A, Vermunt L, et al. The Alzheimer’s disease drug development landscape. Alzheimer’s Res Ther. 2021;13(1):1-9. doi:10.1186/S13195-021-00927-Z/FIGURES/3
12. Cummings J, Lee G, Nahed P, et al. Alzheimer’s disease drug development pipeline: 2022. Alzheimer’s Dement Transl Res Clin Interv. 2022;8(1):e12295. doi:10.1002/TRC2.12295
13. Arber C, Lovejoy C, Wray S. Stem cell models of Alzheimer’s disease: progress and challenges. Alzheimers Res Ther. 2017;9(1). doi:10.1186/S13195-017-0268-4
14. Case Study: A model of Alzheimer’s disease. Accessed August 8, 2022. https://www.ncardia.com/insights/resources/case-study-amodel-of-alzheimers-disease
INTERNATIONAL BIOPHARMACEUTICAL INDUSTRY 41 www.international-biopharma.com
Therapeutics

15. Bassil R, Shields K, Granger K, Zein I, Ng S, Chih B. Improved modeling of human AD with an automated culturing platform for iPSC neurons, astrocytes and microglia. Nat Commun 2021 121. 2021;12(1):1-21. doi:10.1038/s41467-021-25344-6
16. van der Kant R, Langness VF, Herrera CM, et al. Cholesterol Metabolism Is a Druggable Axis that Independently Regulates Tau and Amyloid- β in iPSC-Derived Alzheimer’s Disease Neurons. Cell Stem Cell. 2019;24(3):363-375.e9. doi:10.1016/J. STEM.2018.12.013
17. Di Paolo G, Kim TW. Linking lipids to Alzheimer’s disease: cholesterol and beyond. Nat Rev Neurosci 2011 125. 2011;12(5):284-296. doi:10.1038/nrn3012

18. Kondo T, Imamura K, Funayama M, et al. iPSC-Based Compound Screening and In Vitro Trials Identify a Synergistic Anti-amyloid β Combination for Alzheimer’s Disease. Cell Rep. 2017;21(8):23042312. doi:10.1016/J.CELREP.2017.10.109
19. Kondo T, Banno H, Okunomiya T, et al. Protocol: Repurposing bromocriptine for Aβ metabolism in Alzheimer’s disease (REBRAnD) study: randomised placebo-controlled double-blind comparative trial and open-label extension trial to investigate the safety and efficacy of bromocriptine in Alzheimer’s disease with presenilin 1 (PSEN1) mutations. BMJ Open. 2021;11(6):51343. doi:10.1136/ BMJOPEN-2021-051343
20. Gómez-Benito M, Granado N, García-Sanz P, Michel A, Dumoulin M, Moratalla R. Modeling Parkinson’s Disease With the Alpha-Synuclein Protein. Front Pharmacol. 2020;11:1. doi:10.3389/ FPHAR.2020.00356
21. Ntetsika T, Papathoma PE, Markaki I. Novel targeted therapies for Parkinson’s disease. Mol Med 2021 271. 2021;27(1):1-20. doi:10.1186/S10020-021-00279-2
22. Paton DM. Istradefylline: adenosine A2A receptor antagonist to reduce “OFF” time in Parkinson’s disease. Drugs Today (Barc). 2020;56(2):125-134. doi:10.1358/DOT.2020.56.2.3098156
23. Tabata Y, Imaizumi Y, Sugawara M, et al. T-type Calcium Channels Determine the Vulnerability of Dopaminergic Neurons to Mitochondrial Stress in Familial Parkinson Disease. Stem Cell Reports. 2018;11(5):1171-1184. doi:10.1016/J.STEMCR.2018.09.006
24. Yamaguchi A, Ishikawa K ichi, Inoshita T, et al. Identifying Therapeutic Agents for Amelioration of Mitochondrial Clearance Disorder in Neurons of Familial Parkinson Disease. Stem Cell Reports. 2020;14(6):1060-1075. doi:10.1016/J.STEMCR.2020.04.011
25. Kouroupi G, Antoniou N, Prodromidou K, Taoufik E, Matsas R. PatientDerived Induced Pluripotent Stem Cell-Based Models in Parkinson’s Disease for Drug Identification. Int J Mol Sci. 2020;21(19):1-26. doi:10.3390/IJMS21197113
26. Phase 1 Study of NPT200-11 in Healthy Subjects - Full Text View – ClinicalTrials.gov. Accessed August 8, 2022. https://clinicaltrials. gov/ct2/show/NCT02606682?term=NPT200-11&draw=2&rank=1
27. Fukusumi H, Togo K, Sumida M, et al. Alpha-synuclein dynamics in induced pluripotent stem cell-derived dopaminergic neurons from a Parkinson’s disease patient (PARK4) with SNCA triplication. FEBS Open Bio. 2021;11(2):354-366. doi:10.1002/2211-5463.13060
28. Hardiman O, van den Berg LH. Edaravone: a new treatment for ALS on the horizon? Lancet Neurol. 2017;16(7):490-491. doi:10.1016/ S1474-4422(17)30163-1
29. Wainger BJ, Kiskinis E, Mellin C, et al. Intrinsic Membrane Hyperexcitability of Amyotrophic Lateral Sclerosis PatientDerived Motor Neurons. Cell Rep. 2014;7(1):1-11. doi:10.1016/J. CELREP.2014.03.019
30. Wainger BJ, Macklin EA, Vucic S, et al. Effect of Ezogabine on Cortical and Spinal Motor Neuron Excitability in Amyotrophic Lateral Sclerosis: A Randomized Clinical Trial. JAMA Neurol. 2021;78(2):186196. doi:10.1001/JAMANEUROL.2020.4300
31. Okano H, Yasuda D, Fujimori K, Morimoto S, Takahashi S. Ropinirole, a New ALS Drug Candidate Developed Using iPSCs. Trends Pharmacol Sci. 2020;41(2):99-109. doi:10.1016/J.TIPS.2019.12.002
32. Fujimori K, Ishikawa M, Otomo A, et al. Modeling sporadic ALS in iPSC-derived motor neurons identifies a potential therapeutic agent. Nat Med 2018 2410. 2018;24(10):1579-1589. doi:10.1038/s41591018-0140-5
33. Huang X, Roet KCD, Zhang L, et al. Human amyotrophic lateral
sclerosis excitability phenotype screen: Target discovery and validation. Cell Rep. 2021;35(10):109224. doi:10.1016/J. CELREP.2021.109224/ATTACHMENT/C8F909D5-7D7E-44A3-979E3543B46F44AE/MMC4.XLSX
34. Case Study: Parkinson’s Disease Modeling. Accessed August 8, 2022. https://www.ncardia.com/insights/resources/case-studyparkinsons-disease-modeling
35. Case study: Development of a cardiac hypertrophy iPSC-derived disease model. Accessed August 8, 2022. https://www.ncardia. com/insights/resources/case-study-development-of-a-cardiachypertrophy-ipsc-derived-disease-model
36. Webinar: Robust human iPSC-derived neuronal and glial in vitro drug discovery assays. Accessed August 8, 2022. https://www. ncardia.com/insights/webinars/webinar-robust-human-ipscderived-neuronal-and-glial-in-vitro-drug-discovery-assays
Noelia Muñoz-Martín
Noelia obtained her PhD in biomedical research in 2019 and worked as postdoc before joining Ncardia. She has extensive experience in cardiac arrhythmias and congenital heart disease. Noelia has contributed to science communications of several organizations and companies from different angles, writing and editing peer-review articles and blogs, and creating website and social media content.

Email: noelia.munoz-martin@ncardia.com Web: www.ncardia.com
Shushant Jain
Dr. Shushant holds a PhD in Molecular Genetics of Neuroscience and has significant expertise in developing high-content/ high-throughput assays, automation and data analysis with a strong focus on neurodegenerative diseases. He has led large, multiyear research programs for drug discovery initiatives in several therapeutic areas. Shushant’s research has been published in Neuron, Genome Biology, the Journal of Biomolecular Screening and the Journal of Biological Chemistry, among others.
Email: shushant.jain@ncardia.com Web: www.ncardia.com
42 INTERNATIONAL BIOPHARMACEUTICAL INDUSTRY Spring 2023 Volume 6 Issue 1
INTERNATIONAL BIOPHARMACEUTICAL INDUSTRY 43 www.international-biopharma.com y archive Independent Dedicated Secure Contact us today to find out more 01933 357953 | archives@qualogy.co.uk | www.qualogy.co.uk The Archivist, Qualogy Ltd, Po Box 6255, Thrapston, Northamptonshire, NN14 4ZL Compliant
The One that Gut Away –Measuring Microbial VOCs from Breath
Non-invasive tools that are effective for disease screening, diagnosis and monitoring remain an unmet need in many disease areas. This article discusses breath volatile organic compounds (VOCs) as non-invasive biomarkers, and how breath, in addition to faecal VOCs, has the potential to reflect gut microbial activities, making it highly favourable for clinical application. More importantly, the article highlights an important interaction between gut microbial-produced VOCs and drug action, and by taking this into consideration during drug development, the pharmaceutical industry could improve the efficacy and patient-targeting capabilities of new drugs.
Volatile organic compounds (VOCs) are a large group of carbon-based chemicals that are emitted from biological samples, such as faeces, urine and breath. They include molecules such as short-chain fatty acids (SCFAs) and alcohols, which are well known products of the microbiome. VOCs produced in the body come from cellular metabolic activities, reflecting the physiological state, and have high potential to serve as disease biomarkers. The collection of VOCs from all biological samples is non-invasive, however the measurement of VOCs on breath is preferable over other biological samples for several reasons including; ease of sampling and repeat sampling within a short time frame, samples taken in real-time reflecting metabolic activity at a precise time point, and reduced variability due to standardised sample collection.
Breath VOCs can originate from either within the body (endogenous VOCs) or from external sources including dietary and environmental exposures (exogenous VOCs). Changes to the levels of endogenous VOCs can be characteristic of specific disease processes as they are often products of metabolic activity in the body. However, many metabolites produced by the human body are not derived from human metabolism – they can also originate from microbes within the gut. VOCs produced by microbes in the gut have been studied far less despite these VOCs showing links to several disease areas including gastrointestinal diseases.1,2 Many of the gut microbial-produced VOCs come from the metabolism of dietary fibre. Dietary fibres, which cannot be metabolised by the human body, are fermented by gut microbes, the metabolism of which produces volatile SCFAs and alcohols. Other known volatile microbial metabolites include phenol, phenyl acetaldehyde and p-cresol, which are produced through aromatic amino acid catabolism. Many of these gut microbial-produced VOCs are beneficial to the body and may regulate both local and distant immune, neuronal and metabolic responses. Changes in the levels of these VOCs could therefore imply gut microbiota composition and/or diversity changes, as well as its associated diseases such as cancer, gastrointestinal disorders and cardiovascular disease.
Measuring Gut Microbial-produced VOCs in Breath Faecal headspace analysis, which is the collection and analysis
of components present in the volume of gas above a sample, has been most widely used to understand the role of the gut microbiome in digestive health. However, data from faecal headspace analysis does not reflect real-time metabolic activity and can be delayed by up to 48 hours. Also, variability is introduced due to the quick evaporation of VOCs from headspace samples, and the lack of standardised research protocols makes comparisons between studies difficult. Breath VOCs represent an alternative option as it is reflective of the same gut microbial-produced VOCs found in faeces, with all the aforementioned advantages of sampling and analysis. Taken together, breath analysis has emerged as a highly effective method for both biomarker research and clinical tests.
It is worth noting that whilst breath offers several advantages over faecal sampling, breath VOCs originate from all around the body and are not restricted to the gut. Headspace analysis of faecal samples is therefore a useful tool to first identify VOCs known to be produced in the gut, which can then be used to inform VOC targets in breath sampling. Comparison of the levels in breath and faecal samples can be then undertaken to ensure breath analysis provides an accurate representation of gut behaviour.
Gut Microbial-produced Short Chain Fatty Acids in Patients with Crohn’s Disease
The connection between exhaled breath VOCs and gut microbiota within the same subjects has been demonstrated in Crohn’s disease (CD), a subtype of inflammatory bowel disease (IBD).2 Through breath sample and faecal metagenomics analysis in both active and inactive CD subjects, SCFAs acetate and propionate significantly correlated with Bifidobacteria and several other microbes in the Firmicutes phylum in both disease states. More importantly, the relative abundances of produced SCFAs and the correlated microbial strains both decreased in active disease subjects, indicating how disease state, the gut microbiota and its produced VOCs are connected. Other findings from the study included significant correlations between inflammation VOC biomarkers like pentane and octane, and Bacteroides fragilis and Ruminococcus gnavus in active disease state subjects. While this does not imply the specific VOCs were produced by these bacteria, their level of abundance could share a common cause.
Gut Microbial-produced Ethanol in Non-alcoholic Fatty Liver Disease Patients
Gut microbes can metabolise a variety of diet-derived substrates through microbial fermentation. In liver disease, non-alcoholic fatty liver disease (NAFLD) and non-alcoholic steatohepatitis (NASH) are thought to share a common pathophysiology with alcoholic fatty liver disease (AFLD). Rather than from alcohol intake, it is hypothesised that ethanol exposure in these diseases is due to gut bacteria overproducing ethanol from pyruvate, the end-product of glycolysis. However, peripheral blood concentrations of microbial-derived ethanol generally
44 INTERNATIONAL BIOPHARMACEUTICAL INDUSTRY Spring 2023 Volume 6 Issue 1 Therapeutics
PEER REVIEWED
were deemed negligible compared to the amount of ethanol that can be ingested.
Recent clinical studies have linked the development of NAFLD and NASH to microbial dysbiosis.3,4 Metagenomic analysis correlated specific bacterial populations with high levels of gut ethanol fermentation in subjects with NAFLD and NASH. However, the ethanol produced in the gut is metabolised by hepatic alcohol dehydrogenase before it reaches peripheral circulation, and therefore only a slight elevation of circulating blood alcohol was measured in these individuals when compared to healthy subjects.
Ethanol levels in the portal vein leading from the gut to the liver are elevated by up to 187 times with this increase even more pronounced in NAFLD and NASH individuals.5 Ethanol levels were determined using a selective inhibitor 4-methylpyrazole (4-MP) to inhibit hepatic alcohol dehydrogenase activity (Figure 1), and results showed that microbial-produced ethanol levels in the periphery strongly increased and spiked two-hours after

meal consumption in these subjects relative to healthy subjects without steatosis.
When these subjects with NASH were given a broad-spectrum of antibiotics (metronidazole, clindamycin, ciprofloxacin) for one week to deplete the gut microbiome and ablate the ability for ethanol production after a meal containing carbohydrates, antibiotic treatment nearly completely suppressed peripheral ethanol levels in subjects given the alcohol dehydrogenase inhibitor and a carbohydrate meal (Figure 1). These findings support the idea of the gut microbiome driving overt ethanol production in individuals with NASH. There is therefore a need for a device capable of monitoring microbial-produced ethanol routinely and in a non-invasive manner.
The Importance of Taking Gut Microbial Activity Into Account During Drug Development

It is estimated that subjects with NASH can produce between 7 and 100g of ethanol per day, which is above the guidelines of alcohol intake safety concerns for subjects with NASH. It is concerning that a substantial proportion of NASH subjects should be excluded from the NAFLD category as they are exposed to endogenously produced ethanol, regardless of meeting the inclusion criteria for ethanol intake. This is important especially for the pharmaceutical industry, as large database analysis on prescription medications suggest potential alcohol interaction in 45% of the medications.
There are at least eight classes of new drugs under development for NASH treatment, each acting against different pharmacological targets aimed to alleviate or prevent further disease progression (Figure 2). Many of these drugs target metabolic processes that are exacerbated by chronic ethanol exposure, and therefore ethanol intake is strictly controlled. However, the lack of consideration for gut ethanol production may lead to undesired outcomes during drug development. Not controlling for ethanol produced by gut microbials could contribute to failure during clinical trials or ineffective identification of patient populations that most effectively respond to a given drug, reducing the likelihood of establishing the efficacy of a NASH drug.
INTERNATIONAL BIOPHARMACEUTICAL INDUSTRY 45 www.international-biopharma.com Therapeutics
Figure 1. Ethanol concentration during a mixed meal test (MMT) following 4-methylpyrazole (4MP) infusion and antibiotics (AB) use.
Figure 2. Pharmacological targets for NASH therapy.
While some NAFLD subjects are non-ethanol producers, it has been reported that up to 60% of NAFLD subjects have gut bacteria that produce up to 100g of ethanol per day.3 Given that the beneficial effects of NASH drugs can be counteracted by ethanol, it therefore follows that subjects with ethanol produced in their body would likely have reduced or absent efficacy towards drug response. Additionally, the detrimental effect of ethanol on drug efficacy may lead to a requirement for greater dosages for desired response, causing more side effects and safety concerns. To help identify patients that are more likely to respond to therapy in clinical trials, and to increase the potential of bringing new NASH drugs to market, a diagnostic test for gut ethanol production is an urgent need.
Taking into account the liver’s ability to metabolise ethanol from the portal vein and mask levels in the periphery, blood-breath partition ratios, etc, breath levels of ethanol from gut fermentation are expected to be less than 20 ppb on a volume basis. This means that currently available breath analysers are not sensitive enough, as they can only detect ethanol at levels greater than 100 ppb. Lab-based analytical instruments have the capacity to detect ethanol in the ppq (parts per quadrillion) range in breath samples. Further development of sampling devices will allow for at-home collection and identification of potential disease incidence prior to their first clinical visit.
Conclusion
Breath sampling offers a non-invasive, user friendly alternative to faecal sampling. It provides the same ability to detect gut microbialproduced VOCs, but with an easier and more standardised sample collection process, for use in both research and potential products for gastrointestinal disease detection. With applications ranging from diagnostics of IBD using metagenomics analysis to identifying patients most likely to respond positively in clinical trials, there is a
clear demand for a highly sensitive and accurate breath sampling device to monitor metabolic activity.
REFERENCES
1. van Vorstenbosch, R., et al., Systematic Review: Contribution of the Gut Microbiome to the Volatile Metabolic Fingerprint of Colorectal Neoplasia. Metabolites, 13(1), (2022).

2. Smolinska, A., et al., Volatile metabolites in breath strongly correlate with gut microbiome in CD patients. Anal Chim Acta. 1025, 1-11 (2018).
3. Yuan, J., et al., Fatty Liver Disease Caused by High-Alcohol-Producing Klebsiella pneumoniae. Cell Metab. 30(6), 1172 (2019).
4. Zhu, L., et al., Characterization of gut microbiomes in nonalcoholic steatohepatitis (NASH) patients: a connection between endogenous alcohol and NASH. Hepatology. 57(2), 601-9 (2013).
5. Meijnikman, A.S., et al., Microbiome-derived ethanol in nonalcoholic fatty liver disease. Nat Med. 28(10), 2100-2106, (2022).
Dr. Tina Chou

Tina Chou is a biomarker scientist at Owlstone Medical where she is responsible for supporting customers with study design, data interpretation and report delivery. She is also involved in scientific content writing as part of the Company’s technical sales and marketing efforts. With a PhD degree in Plant Science from University of Connecticut and several years of post-doctoral experience working with omics data in the broader biology field at North Carolina State University, Tina successfully moved into her current role at Owlstone in 2021.
Email: hsuan.chou@owlstone.co.uk
46 INTERNATIONAL BIOPHARMACEUTICAL INDUSTRY Spring 2023 Volume 6 Issue 1 Therapeutics
Recombinant Insulin for upstream processes
Enabling better medicines
Grow your cells with Recombinant Insulin
As the leading supplier of Recombinant Insulin for serum-free and chemically defined cell culture media, we can help you keep development on track and production flowing.


Novo Nordisk Pharmatech A/S remains the best supplier of Recombinant Insulin – beginning with the quality of our Insulin sourced directly from Novo Nordisk, the world’s largest producer.


Manufacturing and quality control, precision delivery and a risk mitigation strategy that assures continuous availability are a few reasons why you should grow your cells with our Recombinant Insulin.
Learn more about our Recombinant Insulin at novonordiskpharmatech.com

INTERNATIONAL BIOPHARMACEUTICAL INDUSTRY 47 www.international-biopharma.com
Multiparticulates: A Flexible Approach for New Dosage Forms
Multiparticulate (MP) technology is a well-established and versatile tool for solving a wide range of drug delivery problem statements, including oral modified and controlled release, developing patient-centric dosage forms, and achieving flexibility in dose and dosage form presentation. MP technology can also be combined with other formulation technologies, such as amorphous forms or permeation enhancement to improve bioavailability in certain cases. With such diversity in potential applications, it is natural to ask when multiparticulates are the ideal choice, and how formulations are selected.
Technology selection to evaluate a multiparticulate approach starts with defining the target product profile (TPP) for a compound. The TPP may encompass technical drivers such as the need to address low bioavailability, pharmacokinetic considerations such as requirements for extended release, or the need for localised delivery in the gastrointestinal tract. External product drivers can also be an important part of the TPP, including product lifecycle management, tailoring dosage forms for specific patient populations, and dose flexibility requirements.
In the earlier stages of clinical development, a range of dose sizes may be required for dose-finding studies, and making a range of different tablets with varying dose strength can add to the complexity of the development process. A single, flexible intermediate such as a multiparticulate would be beneficial if it could be easily pivoted from one presentation to another.
There is a growing market, too, for age-appropriate formulations, particularly for paediatric populations who are unable to swallow a traditional tablet or capsule. For some alternative presentations, taste masking may be essential. In all of these cases, the answer may lie in a multiparticulate design.
Multiparticulates are small, discrete units of formulated drug, each with a uniform fractional dose. Any required functionality is already built-in to each discrete unit. These individual units might be microspheres, pellets, granules, or even mini-tablets, with sizes falling into the 100µm to millimetre size range. It is easy to scale the dose by varying the quantity of the discrete formulated multiparticulates into a particular dosage form, such as a capsule or sachet. In particular, when a modified or controlled release profile is required, this approach can faster and less costly and time-consuming to create dosage forms in multiple different strengths.
Multiparticulate Advantages
A key advantage of multiparticulates is their ability to offer an extremely wide range of release characteristics, which is dictated by the particles’ formulation, size and functional coatings, as shown in Figure 1. Options include immediate release or controlled release lipid multiparticulates, coatings
to provide taste masking, controlled release or pH-dependent properties, or fixed dose combinations by blending multiparticulates made from different compounds together.
Coatings applied to the multiparticulates can confer a variety of benefits. They can be used for taste masking, which is particularly important for sprinkled dosing in paediatric populations. They are also used to protect drugs in the acid environment of the stomach and to enable their release further down the gastrointestinal tract, such as in the jejunum or colon.
Other problems can be addressed with multiparticulates, too. One is avoiding the side-effects caused by plasma spikes with highly soluble immediate release formulations, where multiparticulates can assist via blunting the Cmax . Both modified and controlled release multiparticulates are also able to provide sustained release over prolonged periods to counteract short plasma half-lives. Additionally, multiparticulates can help reduce gastric emptying variability, as they travel more efficiently with gastric fluids and have a more consistent transit into the small intestine than enteric coated monoliths.
Finally, from the perspective of the patient, dosing of multiparticulates in a suspension or in a soft food can avoid the sandy mouthfeel that is all too common in granule-based suspensions because of their small size. The ability to easily taste-mask through functional coatings facilitates further improvements in patient compliance and experience.
Lipid Multiparticulates
There are several types of multiparticulate. A lipid multiparticulate, or LMP, typically preserves the drug’s crystalline form by embedding it within a solid-lipid matrix. LMPs normally fall into the size range 100–400µm. The drug loading can be tuned from 5% to >60%, facilitating dose flexibility. These multiparticulates will normally have good flowability and optimal mouthfeel. Tight particle size control is necessary if acceptable uniformity is to be achieved, which is key to ensuring the required end performance at the desired dose.
A LMP is a network of drug crystals contained within a lipid-based matrix. The network is connected through water-accessible pores created by the inclusion of water soluble polymeric excipients. The release profile of the drug from the matrix is governed by the permeation of water into the core, the dissolution of the drug and the pore-forming excipient, and finally diffusion out of the particle. The rate and nature of release depends on both the lipid properties and excipient ratios. This approach offers a wide range of release rate tunability, with timescales ranging from seconds to months depending on the formulation. Immediate, modified or controlled release are all accessible using this technology.
LMPs are manufactured by a melt-spray-congeal (MSC) process. The first step of the MSC process involves blending
48 INTERNATIONAL BIOPHARMACEUTICAL INDUSTRY Spring 2023 Volume 6 Issue 1 Technology
Harness the power of full spectrum scientific recruitment

Take your research from the laboratory to market with SRG’s agile, full-spectrum recruitment solutions.

SRG provide qualified scientists across all stages of research and development, from clinical trials to manufacture and product release.
Our services include:

Ad-hoc staffing
Help with start-ups
Early talent support
Contract roles
Permanent roles
Executive search
We believe in creating bonds for life with candidates and clients alike, to unlock potential and drive success.
Scan the QR code to explore our services or contact us
www.srgtalent.com
solutions@srgtalent.com
Creating tomorrow's world
lipid excipients with the API, followed by melting and mixing the lipids with the dispersed API, typically through extrusion. The melt suspension is pumped to a spinning disc, where it is atomised. During flight, the molten droplets congeal to form spherical solid particles, which are collected and can be sieved to give more control over the particle size distribution. The base LMP can then be further functionalised by coating before incorporation into a final dosage form.
Spray Layered Multiparticulates and Alternative Approaches
Spray layered multiparticulates (SLMs) comprise layers of drug and/or other functional coatings on the outside of an inert core made from an excipient such as microcrystalline cellulose or sucrose. They are created via a fluid bed coating process, and are compatible with both crystalline and amorphous forms of the drug. Sizes range from about 200µm to 1mm, depending on the thickness of the coating. Drug loadings as low as <1.0% and up to 40% can be achieved.
SLMs can be manufactured to target both crystalline and amorphous forms of the drug. For a crystalline form of the API, the drug may be sprayed layered in the fluid bed coating process as a fully dissolved solution, or as a suspension with a binder. In this case, spray solutions are designed to either crystallise the drug during drying, or to layer intact drug crystals form a suspension.
Similarly, an amorphous SLM is manufactured by dissolving the crystalline API with a polymer excipient. Here, the spray solution formulation and fluid bed coating process are both designed to maintain a soluble form of the drug that will become amorphous upon drying. In all cases, the API formulation is coated onto the substrate until the desired weight gain is achieved.
Additional coatings can also be layered onto the SLMs to alter their functionality or design. The coating might be simply cosmetic or protective, but equally it could provide a modified release profile of some form. The result is a batch of flowable particles whose functionality can be tuned by the layering.
It is also possible to make pellets using alternative technologies such as wet granulation and spheronisation, with typical sizes of 0.5–1.5mm, and slightly larger mini-tablets, with particle sizes of about 1.5–3.0mm. Both of these can
readily achieve drug loadings of 10–80%. Utilisation of these alternative approaches, particularly mini-tablets, may be useful for content uniformity control, and to maintain parity with existing commercial capabilities.
Dosage Forms
The multiparticulate approach opens the door for manufacturing a variety of different dose presentations, tailored to the development phase or target population. The wide range of different dosage forms that can incorporate multiparticulates gives a huge amount of flexibility in both presentation and dosage size. As well as simply filling them into a capsule, they can be incorporated into dosage forms as diverse as suspensions, sachets and sprinkle capsules, orally disintegrating tablets, and even syringe-based dosing devices.
For higher doses, sachets are often appropriate, as they are easily to fill with multiparticulates rather than powders. The sprinkle capsule is similarly appropriate for the paediatric market, where the capsule is designed to be opened rather than swallowed and the contents sprinkled onto food. Pre-filled syringes or pre-measured dosing spoons can also be used for oral administration. All of these are, of course, customizable.
Suitable presentations for children are increasingly important in the light of the regulators’ demands for companies to develop age-appropriate dosage forms, and perform paediatric clinical studies for most developmental drugs. The aim here is to reduce future off-label use in children.
Selecting the Best Option
The first step in determining whether to utilise a multiparticulate intermediate is to consider the patient population, the desired final dosage form, and the required drug properties. Could multiparticulates help achieve the target product profile? A good understanding of the compound itself will inform the choice of multiparticulate type, including its physicochemical properties, pharmacokinetics and bioavailability. Dose size (including for clinical work), dosing requirements (including patient-centric concerns), and ultimate product target requirements can all have an impact. The technology options for manufacturing multiparticulates can be narrowed down by considering the particle size, geometry and drug loading of the different manufacturing techniques, as shown in Figure 2.

50 INTERNATIONAL BIOPHARMACEUTICAL INDUSTRY Spring 2023 Volume 6 Issue 1
Technology
Figure 1
This information provides the backdrop to an evaluation of the inclusion criteria for an LMP or an SLM over a more traditional formulation. From a physical perspective, a multiparticulate might be desirable if the API has poor flow properties. Looking at bioavailability and the target product profile, is an amorphous form or a tailored release product required for stability, patient or pharmacokinetic reasons? And finally, are the patients likely to have difficulty swallowing larger dosage forms, or will a range of different forms be necessary to cover all eventualities?
Next, which is more appropriate, an LMP or an SLM? A closer assessment of more physical characteristics underpinning feasibility and stability is required. For an LMP, a screen of lipid melt systems will ensure effective suspension and stability are achieved at the required temperatures. Amorphous and crystalline solubility is a critical factor in determining whether an SLM is a better choice. Finally, in both cases, compatibility with common lipid and coating excipients should be considered to ensure there is no adverse reaction with the API.
When an initial approach has been selected, the next step is to evaluate the feasibility of the process for the product. For LMPs, melt rheology will be studied, with a focus on viscosity and atomisation properties. Congealing rate is also assessed to ensure there is adequate particle formation and collection. With an SLM, the focus is more on the properties of the active films with the binder or as a dispersion, as well as suspension or solution properties related to spray atomisation for the coating process. The use of model-based guidance, such as defining atomisation regimes or predicting and defining phase diagrams, are recommended as part of these feasibility approaches.

Taking this systematic approach ensures that the move from concept to prototype occurs as quickly as possible. Ratios can be adjusted to fine-tune release, as can the choice of excipients. And, of course, any requirement for further functionalisation of its release and stability properties via coating can be addressed.
There are, clearly, occasions where a simple granulated API compressed into a tablet or filled into a regular capsule will be the easiest and cheapest option for achieving the target product profile. But in the right circumstances, some form of multiparticulate dosage form can be the ideal choice, giving good uniformity, flexibility of dosage size, and an easy way to achieve a patient-appropriate dosage form.
Jon started his journey with Bend Research in 2011 as a Sr. Research Chemist and Principal Scientist after postdoctoral research focusing on redox catalysis at both Washington State Dept. of Chemistry and Los Alamos National Laboratory, Materials Chemistry Group. Jon has a Ph.D. in Biochemistry and Biophysics from the School of Molecular Biosciences/ Washington State University and a B.S. in Biology from New Jersey City University. He has 24 peer reviewed articles and 4 patents/patent applications along with a record of achievements in spray dried dispersions including ternary phase modeling, heated solvents and alternative solubilization approaches, several of which resulting in customer use, patents, or publications.
Joel Wood

Joel is a Product Development Engineer at Lonza’s site in Bend, Oregon, USA, where he focuses on late-phase process and product development. During his time at Lonza, he has worked as an engineer large-scale spray-drying systems and as engineering lead on late-phase programs for spray-dried dispersions and multiparticulate technologies. His areas of expertise include process scale-up methodology, control strategy development, and technology transfer of late-phase clinical and commercial products, including those made with spray drying.
 Hannah Sullivan
Hannah Sullivan
Hannah has worked at Lonza for 8 years, having started in the Global Research and Development group located in Bend, Oregon, and then progressing to an engineering role in the Product Development group. Hannah has a BS in Chemical Engineering from New Mexico Institute of Mining and Technology. She has made numerous contributions to spray drying and multiparticulate technologies while at Lonza, both in basic research and customer-facing roles, and is currently focused on commercialization of multiple multiparticulate programs.

INTERNATIONAL BIOPHARMACEUTICAL INDUSTRY 51 www.international-biopharma.com
Figure 2
Jonathan Cape
Technology
REGISTER
To find out more and to register please scan the QR code or visit elrig.org.
ELRIG THERAPEUTIC OLIGO AND EUROPEAN CHEMICAL BIOLOGY SYMPOSIUM 2023
9TH - 11TH MAY
ASTRAZENECA, GOTHENBURG
TRACK TITLES
Therapeutic OLIGO profiling
Advancements in OLIGO design and synthesis
Novel formulations and biomarker analysis

Chemical probe-induced protein interaction and degradation
New ways to shape and interrogate biology through chemistry
Innovative tools and methods for advanced cell profiling
FREE TO ATTEND
DISCOVERY TECHNOLOGIES 2023: COMPLEX MEDICINES FORUM



20TH JUNE
REGISTER
To find out more and to register please scan the QR code or visit elrig.org
Drug delivery systems for the next generation of therapeutics
Although small molecule therapeutics still account for 90% of approved medicines, patient expectations are increasingly driving the industry towards targeted, precision treatments and new therapeutic modalities, which often require sophisticated delivery technologies to be effective medicines.
ELRIG are partnering with the European Technology Platform on Nanomedicine (ETPN), British Society for Nanomedicine and the University of Liverpool at Nanomed Europe #NME23.
With representatives from big pharma and biotech the ELRIG session will concentrate on the challenges of R&D in nanomedicines from an industry perspective. Covering a range of modalities, it will explore how drug dendrimer conjugates can improve the properties of small molecule therapeutics, discuss developing a lipid nanoparticle drug delivery platform for distinct diseases and report progress in the targeted delivery of exosomes.
SPEAKERS
Arpan Desai, Nanovation Therapeutics UK
Marianne Ashford, AstraZeneca

Sally Price, Evox Therapeutics
LIVERPOOL elrig
elrig.org
@ELRIG_UK
52 INTERNATIONAL BIOPHARMACEUTICAL INDUSTRY Spring 2023 Volume 6 Issue 1
elrig @EuChemS @EU-OPENSCREEN @ELRIG_UK @EuChemS @EuOpenscreen elrig.org euchems.eu eu-openscreen.eu



















































































































INTERNATIONAL BIOPHARMACEUTICAL INDUSTRY 53 www.international-biopharma.com LONDON APRIL25 -26 2023 CATALYSING GROWTH IN THE LIFE SCIENCES INDUSTRY www.BioTrinity.com @BioTrinity #BioTrinity Organised by


54 INTERNATIONAL BIOPHARMACEUTICAL INDUSTRY Spring 2023 Volume 6 Issue 1 Asia’s premier pharmaceutical event 19-21 June 2023 | Shanghai New International Expo Center To register please visit www.cphi.com/china Contact salesoperations@informa.com China’s pharmaceutical market is forecast to expand from CNY1.07trn (USD155.1bn) in 2020 to CNY1.3trn (USD203.8bn) by 2025. 50,000+ Pharmaceutical professionals 3,000+ Exhibiting companies 80+ Conferences & activities

INTERNATIONAL BIOPHARMACEUTICAL INDUSTRY 55 www.international-biopharma.com Your gateway to the Japanese market
2023
More information at cphi.com/japan CPHI Japan is the ideal business platform for international pharma professionals to join in order to grow business in the rapidly changing Japanese pharmaceutical market. 20,000+ Attendees 90+ Countries in attendance 420+ Exhibitors
19-21 April
Tokyo, Japan
Page 3 & 32–35
Page 53
Page 37
Page 39
Page 53
Page 54
Page 55
Page 52
OBC
Page 23
Page 5
Page 47
Page 15
IBC
Page 9
Page 19
Aldevron LLC
Anglo Nordic Life Science Conference
Biopharma Group
Biotech i Kungsbacka AB
BioTrinity 2023
CPHI China
CPHI Japan
ELRIG UK
FUJIFILM Wako Chemicals USA
GenXPro GmbH
Life Science Group
Novo Nordisk Pharmatech A/S
Owen Mumford Ltd.
Oxford North
PCI Pharma Services
Precision for Medicine
Page 43 Qualogy Ltd
IFC Recipharm AB
Page 13
Richter-Helm Biologics GmbH & Co. Kg
Page 27 SGS
Page 49 SRG
Page 10 & 11
Sonotec GmbH
I hope this journal guides you progressively, through the maze of activities and changes taking place in the biopharmaceutical industry

IBI is also now active on social media. Follow us on:
www.facebook.com/Biopharmaceuticalmedia www.plus.google.com/biopharmaceuticalmedia www.twitter.com/biopharmace www.biopharmaceuticalmedia.tumblr.com/
56 INTERNATIONAL BIOPHARMACEUTICAL INDUSTRY Spring 2023 Volume 6 Issue 1
Subscribe today at www.international-biopharma.com or email info@senglobalcoms.com
Ad Index

INTERNATIONAL BIOPHARMACEUTICAL INDUSTRY 57 www.international-biopharma.com
building a sustainable new place for Oxford. It will be a unique home and workplace for scientists, technologists, and inventors, transforming lives and the city. Find out more oxfordnorth.com
We’re
Creating the life sciences community of the future
• Colorimetric method, can be used with an absorbance plate reader
• 3-Factor system mimics the same cascade reaction as traditional LAL
• Endotoxin-specific reagent eliminates the risk of false positives from (1-->3)ß-D-Glucan

• 100% animal free
• Quantitative range: 0.001 to 50EU/mL
• High sensitivity with less lot-to-lot variation
• Stable storage after dissolution (4 hrs. at 2-8°C and 2 weeks at -30°C)
Recombinant Endotoxin Detection Reagent

58 INTERNATIONAL BIOPHARMACEUTICAL INDUSTRY
Neo PYROSTAR ™
www.wakopyrostar.com ~ wkuspyrostarinfo@fujifilm.com FUJIFILM Wako Chemicals U.S.A. Corp. © FUJIFILM Wako Chemicals U.S.A. Corp. - 2023 PYROSTAR™ Neo is a new endotoxin detection reagent developed by recombinant technology.

Hannah Sullivan
Hannah Sullivan


















































































